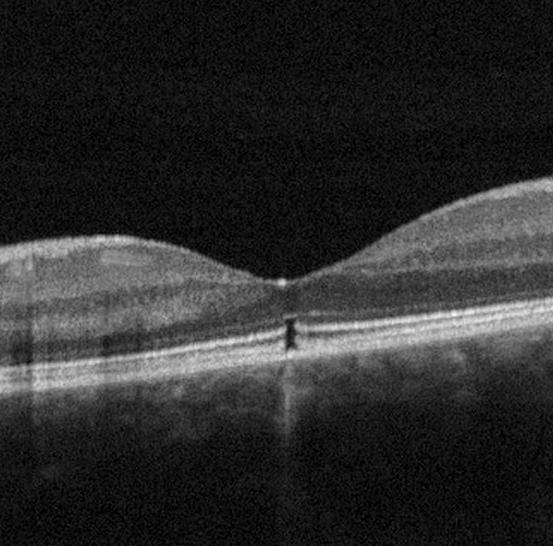
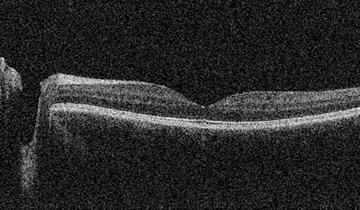
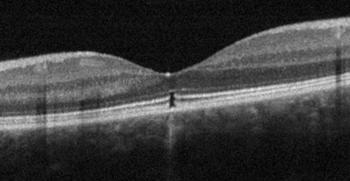

ARTICLE 1
La kératite herpétique bilatérale
ARTICLE 2
Dans le viseur : publications récentes en optométrie
![]()

ARTICLE 1
La kératite herpétique bilatérale
ARTICLE 2
Dans le viseur : publications récentes en optométrie

info@fondsfmoq.com | fondsfmoq.com

5 7
EDITORIAL
Avenir et efficacité clinique
Docteur Guillaume Fortin
Optométriste, Président

ARTICLE 2

ARTICLE 1
La kératite herpétique bilatérale
Dre Rossana Popdoneva Optométriste

CAS CLINIQUE
24 CHRONIQUE JURIDIQUE
Acheter un immeuble sans garanties légales : un pari risqué
Me Frédéric Comeau, Avocat
28
CHRONIQUE FONDS FMOQ
Actifs réels : quelle place dans un portefeuille équilibré?
Monsieur Patrick Murray, CIMMD, FCSIMD, Directeur Placements, Fonds FMOQ
30 CHRONIQUES LUSSIER
L’examen médical en assurance : pourquoi est-ce une étape clé?
31 CHRONIQUES LUSSIER
Transport d’équipement : Votre précieux matériel est-il en sécurité dans votre coffre?
32 CHRONIQUES MNP
Votre clinique est-elle à risque?
Madame Corey Anne Bloom, Monsieur Simon Gaudreau
34 PETITES ANNONCES
Dans le viseur : publications récentes en optométrie
Maculopathie de Best
Docteure Emanuelle Bédard, Optométriste, M.Sc. 13 20
Dr Kevin Messier
Optométriste
ÉDITEUR
Association des Optométristes du Québec 1255, boul. Robert-Bourassa, bureau 1400 Montréal, Québec H3B 3X1 aoq@aoqnet.qc.ca
PRÉSIDENT
Docteur Guillaume Fortin, optométriste
COORDONNATEUR SCIENTIFIQUE
Docteur Kevin Messier, optométriste
COORDONNATRICE DE LA PRODUCTION
Josée Lusignan
514 288-6272
josee.lusignan@aoqnet.qc.ca
PUBLICITÉ
Émilie Pilon Gestionnaire de compte
450 227-8414, poste 310 epilon@cpsmedia.ca
CONCEPTION GRAPHIQUE BooDesign.ca
Les petites annonces classées de l'AOQ
38 CHRONIQUE CAS ET PHOTO MYSTÈRE
Quel serait votre diagnostic ?
ENVOYEZ VOS ARTICLES À L’ÉDITEUR
Revue l’Optométriste 1255, boul. Robert-Bourassa, bureau 1400 Montréal, Québec H3B 3X1
TÉLÉPHONE | 514 288-6272
COURRIEL | aoq@aoqnet.qc.ca
SITE INTERNET | www.aoqnet.qc.ca
Bibliothèque nationale du Québec 2e trimestre 1979. Reproduction interdite sans autorisation.
LE PRÉSENT NUMÉRO A ÉTÉ TIRÉ À 3 050 exemplaires
ISSN-0708-3173
Numéro de convention postale 41129579
ABONNEMENT ANNUEL
CANADA | 85,45 $
ÉTRANGER | 125 $ (taxes incluses)
Articles demandés : L’Optométriste ouvre ses pages à toute collaboration pouvant intéresser la profession optométrique sur le plan professionnel, social, économique et syndical. Le Comité de rédaction invite tous les optométristes à soumettre le rapport d’un cas ou un article susceptible d’intéresser leurs confrères. Tous les écrits soumis deviennent la propriété de la revue l’Optométriste. Le Comité de rédaction se réserve le droit de publier un article dans le numéro qui lui convient. Aucune indemnité ne sera versée à l’auteur pour l’utilisation d’un article. Les textes ainsi que les publireportages publiés dans cette revue n’engagent que leur auteur.
Définition de l’optométriste : « L’optométriste (O.D.) est un professionnel de la santé de première ligne, détenteur d’un doctorat universitaire de 5 ans, qui agit comme porte d’entrée des services oculo-visuels. Il évalue la vision, la binocularité et la santé oculaire. Son rôle est de procéder à l’examen des yeux et de la vision. Il peut également prescrire et administrer des médicaments aux fins de l’examen de la vision et du traitement de certaines pathologies oculaires. Il prescrit les lentilles ophtalmiques nécessaires, qu’elles soient cornéennes ou pour lunettes, et des traitements de rééducation visuelle. L’optométriste prodigue des conseils afin de prévenir les troubles visuels et de promouvoir la saine santé oculovisuelle de ses patients et, au besoin, il peut diriger le patient vers d’autres professionnels de la santé. »

Par le docteur Guillaume Fortin
Optométriste, Président

Comme vous le savez, en novembre dernier, l’Association a procédé à une planification stratégique. Une fin de semaine de réflexion sur les enjeux présents et futurs de notre profession. De quoi inspirer un ou deux textes éditoriaux! Outre la question du contrôle de notre secteur par des intérêts non optométriques que nous avons souvent abordée ces derniers mois, ce fut également l’occasion d’aborder d’autres enjeux et transformations susceptibles d’avoir un impact, qu’il soit positif ou négatif, sur les optométristes.

L’un de ces enjeux majeurs, présent dans plusieurs régions, concerne le temps d’attente pour obtenir un rendez-vous de routine. En effet, de nombreuses discussions avec nos membres font état de deux à six mois d’attente pour des examens dans certaines régions. Cette problématique n’est pas propre à notre secteur, évidemment. Dans ces villes ou régions, il arrive fréquemment que les dentistes, les comptables et les notaires ne prennent plus de nouveaux clients! Cependant, il convient de nuancer, comme nous l’avons souvent souligné par le passé : les « pénuries » sont souvent sectorielles et temporaires. Par exemple, une MRC de 36 000 habitants nécessite généralement la présence de 6 ou 7 optométristes à temps plein pour assurer un service optimal. Si deux d’entre eux partent à la retraite, la MRC se retrouve alors en situation de « pénurie sectorielle », ce qui entraînera une augmentation continue des délais d’attente pour les 4 ou 5 optométristes restants. Du moins jusqu’à ce que deux jeunes optométristes s’établissent dans la MRC et que le problème soit ainsi réglé. Le scénario inverse se produit si trois jeunes optométristes viennent s’établir. La MRC se retrouvera avec une offre supérieure à la demande et alors, oui, les optométristes manqueront potentiellement de travail! L’objectif ici est de comprendre que dans plusieurs régions où les délais d’attente sont longs, l’ajout d’une dizaine d’optométristes règlerait le problème pour de nombreuses années! Cela dit, devant ce type de situation, les optométristes sont et seront de plus en plus incités à trouver des solutions pour améliorer leur efficacité sans compromettre la qualité des soins. Certaines solutions ont déjà été mises en place. La téléoptométrie est une solution qui peut être adoptée, mais elle ne peut pas à elle seule satisfaire tous les besoins, particulièrement en matière de soins de première ligne d’urgence. De plus, bien que la téléoptométrie soit une solution viable, il est difficile de l’envisager comme une solution à long terme dans un contexte clinique où des optométristes sont disponibles sur place toute l’année pour leur communauté. Cela concerne à la fois les patients, qui ont droit à des services optimaux, et la collégialité et la responsabilité des optométristes envers les patients de la clinique.
Nos membres propriétaires, ainsi que plusieurs groupes, ont sollicité des optométristes « volants », exprimant ouvertement leur espoir de les voir s’établir dans leur région. En effet, bien que l’optométrie volante soit souhaitable pour les régions très isolées dépourvues de services, elle n’est pas optimale à long terme lorsque des optométristes sont présents toute l’année pour prendre en charge les cas complexes ou chroniques, dont le suivi peut être affecté par la présence intermittente d’un collègue. Aussi, de nouvelles technologies font leur apparition et permettront peutêtre une amélioration de l’efficacité des cliniques. Nous l’avons mentionné à maintes reprises, en l’absence de main-d’œuvre, nos membres en région n’auront d’autre option que d’innover. Il y a quelques décennies, l’autoréfractomètre, les champs visuels automatisés, les tonomètres sans contact et les caméras de fond d’œil n’existaient pas. Ces technologies ont permis d’améliorer l’efficacité et la précision des examens. L’optométrie évolue constamment et il est possible que certaines mesures, voire certaines analyses diagnostiques, soient réalisées par des systèmes automatisés à l’avenir.
La profession se questionne déjà sur ce qui pourrait être délégué à du personnel d’assistance. Une chose est certaine : entre de mauvaises mains, la technologie et l’intelligence artificielle peuvent engendrer des conséquences néfastes tant pour les patients que pour notre profession. Toutefois, il pourrait être nécessaire d’accepter encore des changements, qu’ils soient technologiques ou règlementaires, pour permettre aux patients de certaines régions du Québec de consulter un optométriste en moins de 4 mois!
Il faut rester vigilants. Que ce soit en ce qui concerne les systèmes de réfraction automatisés de plus en plus performants, les systèmes d’analyse d’imagerie utilisant l’intelligence artificielle, ou une délégation élargie de certains actes à du personnel d’assistance, l’optométriste doit demeurer au cœur de ces évolutions. Il devra en être entièrement responsable. Tout comme le passage des écrans tangents aux champs automatisés il y a 30 ans, ou le remplacement de la majorité des rétinoscopies par l’autoréfractomètre, les avancées actuelles ne doivent en aucun cas sortir du cadre des soins de premières lignes complets fournis par les optométristes. Tout comme pour la téléoptométrie, il sera essentiel d’établir une règlementation rigoureuse pour encadrer les changements à venir.
POUR NOUS JOINDRE
514 288-6272
1 888-SOS-OPTO
Votre message devant les bons yeux.
PRESCRIPTION :
Votre prochaine vente commence ici.
Émilie Pilon epilon@cpsmedia.ca 450 227-8414, poste 310
L’Association est disposée à soutenir toute initiative visant à aider ses membres à accroître l’efficacité de leurs activités cliniques et à améliorer l’accès aux soins pour les patients là où cela est nécessaire. Cependant, en aucun cas l’Association n’acceptera que des avancées technologiques ou un élargissement de la délégation des actes conduisent à fragmenter l’examen complet en procédures « autonomes » qui pourraient être réalisées dans un contexte où aucun optométriste n’exerce un contrôle total…
Quelles que soient les évolutions à venir pour l’optométrie, la force de notre profession doit demeurer l’accessibilité et le lien avec nos patients. Toute « avancée » technologique ou tout changement qui réduirait ce lien constituerait un pas en arrière. Plus que tout, il est impératif que le contrôle total et la responsabilité complète concernant le résultat final de notre expertise restent inébranlables : cela inclut l’ordonnance ainsi que les conseils dispensés aux patients.

Docteur Guillaume Fortin, optométriste Président
DES QUESTIONS ?
écrivez-nous à aoq@aoqnet.qc.ca
FAIRE UN CHANGEMENT D'ADRESSE
Rendez-vous sur le portail de l'AOQ | aoqnet.qc.ca



La majorité des humains seront exposés au virus de l’herpès simplex (HSV), lequel persistera à l’état latent dans leurs ganglions nerveux, le plus souvent dans le ganglion trigéminal. En cas de réactivation, le virus peut atteindre l’œil en parcourant la branche ophtalmique (V1) du nerf trijumeau. Par ailleurs, la kératite herpétique est la principale cause infectieuse de cécité cornéenne dans le monde. Le virus de l’herpès simplex de type 1 est le plus souvent à l’origine d’une atteinte oculaire. Le HSV-1 se transmet par contact direct ou par gouttelettes et se manifeste généralement par des boutons de fièvre autour de la bouche. Généralement, les atteintes oculaires seront unilatérales. Dans de rares cas, les patients peuvent présenter une kératite herpétique bilatérale.
Première consultation :
Une femme caucasienne de 22 ans s’est présentée le 5 août 2024 pour un examen d’urgence, se plaignant principalement d’une vision floue de l’œil droit depuis deux mois. La patiente n’a signalé aucune douleur, photophobie ou rougeur, ni aucun écoulement aqueux.
Dans son dossier, on observe un antécédent oculaire de kératite herpétique droite en mai 2024. La patiente ne rapporte aucun antécédent d’herpès buccal. Lors de sa première visite à notre clinique en mai, elle a été traitée par un collègue avec du valacyclovir oral à 1000 mg deux fois par jour pendant deux semaines, puis à 500 mg deux fois par jour pendant un mois. Elle a aussi reçu de l’Eyezirgan (gel ophtalmique à base de ganciclovir) cinq fois par jour pendant une semaine. On a prescrit le Pred Forte 1 % topique lors du premier suivi, avec un sevrage étalé sur 5 semaines. Elle ne s’est jamais présentée à son deuxième suivi, mais a déclaré avoir terminé le traitement comme prescrit à ce moment. À l’examen oculaire, ses meilleures acuités visuelles corrigées sont de 20/25 OD et 20/20 OS avec une faible prescription hypermétropique. Les pupilles sont égales, rondes et réactives à la lumière, sans défaut pupillaire afférent relatif OU. L’examen à la lampe à fente révèle des paupières saines et une conjonctive bulbaire et palpébrale claire et lisse bilatéralement. Sur la cornée droite, on observe des microkystes épithéliaux centraux avec une opacification stromale cornéenne (« haze cornéen ») de grade 1+ recouvrant la zone pupillaire. La cornée gauche est claire. La chambre antérieure droite est profonde et de rares cellules sont observées, tandis que la chambre antérieure gauche est calme. Aucun effet de Tyndall (« flare ») ni précipité kératique n’est noté. L’iris est plat et ne présente aucun nodule inflammatoire ni atrophie. De la fluorescéine sodique est instillée dans les deux yeux. Aucune coloration cornéenne n’est observée. Les pressions intraoculaires obtenues à l’aide du tonomètre Goldmann sont de 12 mm Hg OD et 13 mm Hg OS.
La présence de microkystes épithéliaux indique une kératite épithéliale active. Puisqu’un antécédent de kératite herpétique à l’œil droit est connu, une réactivation du virus est à suspecter. Le traitement doit donc inclure une couverture antivirale.
On prescrit un traitement de Pred Forte 1 % QID x 1 semaine OD, réduit progressivement à TID, BID et DIE pendant un total de quatre semaines. On ajoute du Valtrex 1000 mg PO BID pendant deux semaines, puis 500 mg BID pendant deux semaines supplémentaires avant d’atteindre une dose finale de 500 mg DIE pendant une période prolongée de six mois. Un suivi d’une semaine est recommandé.
La patiente ne s’est jamais présentée à son suivi d’une semaine. Elle est revue pour la deuxième fois près de quatre semaines après sa visite en urgence. Elle rapporte avoir été malade la semaine précédente et ressentir un nouvel inconfort, une sensation de corps étranger et une vision floue dans son œil gauche depuis quelques jours. Elle assure d’avoir bien suivi le traitement qui lui a été prescrit. Son acuité visuelle corrigée est de 20/20 OD et 20/20 OS. Elle confirme l’amélioration de la vision de son œil droit. L’examen à la lampe à fente de l’œil droit révèle la présence de nouveaux microkystes épithéliaux paracentraux en nasal. Le haze stromal central est moins dense. L’examen de l’œil gauche met en évidence une lésion dendritique épithéliale bien définie traversant le centre de la cornée, sans haze ni œdème cornéen associé. La conjonctive de l’œil droit est claire, contrairement à une légère hyperémie bulbaire à l’œil gauche. La chambre antérieure droite est calme, tandis que de rares cellules sont observées à gauche. À l’instillation de fluorescéine, une coloration épithéliale est notée au niveau du quadrant nasal de la cornée droite, correspondant aux nouveaux microkystes. À gauche, une prise de fluorescéine dendritique est observée. Les pressions intraoculaires sont de 15 mm Hg OD et 18 mm Hg OS.
En raison des nouvelles prises de fluorescéine à la cornée droite, on arrête immédiatement le sevrage de Pred Forte 1 %. La dose orale de valacyclovir est augmentée à 1 000 mg deux fois par jour pendant deux semaines supplémentaires.
Lors du suivi deux semaines plus tard, la patiente rapporte une amélioration bilatérale de sa vision estimée à environ 85 % et une sensation intermittente de brûlement oculaire. Son acuité visuelle est de 20/20 OD et 20/20 OS. L’examen à la lampe à fente ne révèle aucune hyperémie bulbaire ou palpébrale. L’iris est toujours sain, sans atrophie ni signe d’inflammation. La chambre antérieure est calme dans les deux yeux. Lors de l’examen de la cornée à la fluorescéine, une coloration subtile persiste au niveau des lésions dendrites épithéliales refermées des deux yeux. On observe un haze cornéen sous-épithélial le long de celles-ci.
On entreprend un traitement topique de Pred Forte 1 % dans les deux yeux, à raison de trois fois par jour pendant une semaine, puis deux fois par jour la semaine suivante, et une fois par jour une troisième semaine. Le traitement oral de valacyclovir 1000 mg BID est poursuivi pendant deux semaines supplémentaires. Pour soulager la sensation de brûlure, du I Drop Pur QID est prescrit.
Lors de son troisième suivi un mois plus tard, la patiente note un retour à la normale complet de sa vision et l’absence de nouveaux symptômes. Son acuité visuelle reste stable. L’examen à la lampe à fente révèle des dendrites fantômes bilatérales avec un haze cornéen léger, sans microkystes ou coloration à la fluorescéine. La chambre antérieure est calme dans les deux yeux. La dose de maintien est augmentée à 500 mg BID, compte tenu des nombreuses récidives, pour une durée de six mois.
On revoit la patiente 7 mois plus tard. On ne note aucun changement à sa condition. On lui recommande de poursuivre le traitement prophylactique de Valtrex 500 mg BID à long terme et de consulter son médecin de famille annuellement pour surveiller sa fonction hépatique et rénale.
Généralement, le diagnostic d’herpès simplex est posé cliniquement, sans recourir à des tests de laboratoire. Par conséquent, des erreurs de diagnostic peuvent se produire. L’herpès oculaire est surnommé le « grand imitateur », car ses signes et symptômes miment souvent d’autres affections oculaires. La kératite herpétique unilatérale ou bilatérale peut être confondue avec une kératite virale, une érosion cornéenne, une lésion chimique, une kératopathie neurotrophique, un port excessif de lentilles de contact souples, une kératite toxique, une kératite ponctuelle superficielle de Thygeson, une ligne de régénération cornéenne après une abrasion ou certaines dystrophies cornéennes. L’inverse est également possible. En effet, selon la littérature, la kératite à Acanthameoba est le plus souvent diagnostiquée à tort comme une kératite herpétique unilatérale qui ne répond pas au traitement antiviral1. D’autres données publiées montrent qu’un nombre important de patients diagnostiqués avec une kératite herpétique bilatérale souffraient en fait d’une kératite cornéenne causée par un adénovirus, un cytomégalovirus, un entérovirus, le virus d’Epstein-Barr ou le virus varicelle-zona6, 11
Si nécessaire, le HSV peut être confirmé par réaction en chaîne par polymérase (PCR). On peut aussi procéder à une culture virale. D’autres tests diagnostiques sont disponibles, tels que l’immunofluorescence directe (DFA) ou la sérologie 6, 11
Discussion :
L’herpès simplex est l’une des infections oculaires les plus courantes et l’une des principales causes de cécité dans le monde. Au Canada, 89 % de la population a été exposée au HSV-1 qui provoque généralement des lésions buccales. Le virus se transmet principalement par contact direct avec les muqueuses infectées, les lésions cutanées ou les sécrétions de patients symptomatiques ou asymptomatiques. La kératite herpétique bilatérale est beaucoup moins fréquente, avec une incidence similaire chez les hommes et les femmes, variant de 1,3 % à 12 %6
Lors du premier contact du HSV-1 avec l’œil, généralement pendant l’enfance, le virus pénètre l’épithélium cornéen par des récepteurs spécifiques et se réplique. L’infection primaire reste non diagnostiquée chez deux tiers des patients. Parmi le tiers restant, l’infection oculaire initiale se manifeste par une conjonctivite dans 84 % des cas, une blépharite avec éruption de vésicules palpébrales dans 38 % des cas et une kératite dans 15 % des cas. La primo-infection est généralement autolimitante. Dès le premier contact, le virus migre le long des branches sensorielles du nerf trijumeau jusqu’au ganglion trigéminal où il entre alors dans un état latent et stocke son génome dans les cellules hôtes. En cas de réactivation, le virus se réplique et retourne vers la cornée 6, 11
L’herpès simplex oculaire peut se manifester sous différentes formes. Chaque couche de la cornée peut être affectée. La kératite épithéliale est l’une des manifestations les plus courantes. Elle est causée par le virus HSV qui se réplique activement dans les cellules épithéliales de la cornée, provoquant des lésions ponctuées ou dendritiques pouvant entraîner des ulcères géographiques. Des microkystes épithéliaux peuvent également être observés. La kératite stromale se divise en deux formes principales : la kératite interstitielle, également appelée kératite immunitaire ou non nécrosante, et la kératite stromale nécrosante. La forme immunitaire n’est pas associée à une réplication virale active dans la cornée. Elle résulte d’un mécanisme immunitaire qui entraîne une opacification stromale par infiltration de globules blancs. On peut aussi observer un œdème stromal. La forme nécrosante est une réaction immunitaire combinée à une réplication virale active provoquant une destruction tissulaire directe et une ulcération. Les deux formes de kératites stromales s’accompagnent souvent d’une néovascularisation. La réaction inflammatoire de l’endothélium causée par le HSV est appelée endothélite. Elle se caractérise par un œdème stromal associé à des précipités kératiques sur l’endothélium sous-jacent et une réaction de la chambre antérieure. L’endothélite se divise en trois sous-groupes : disciforme, diffuse ou linéaire. La pression intraoculaire est aussi élevée en cas de trabéculite6, 11, 14
Les symptômes rapportés par les patients sont souvent l’œil rouge, l’épiphora, une irritation, une sensation de corps étranger ou une photophobie. La vision peut également être affectée.
La kératite herpétique est généralement unilatérale. L’atteinte cornéenne bilatérale est rare et plus fréquente chez les patients immunodéprimés. Néanmoins, certains patients immunocompétents peuvent présenter des lésions herpétiques bilatérales.
L’immunodéficience est un facteur de risque majeur d’infection bilatérale par le HSV. Ses causes sont nombreuses : maladies auto-immunes, infections virales, transplantations d’organes, etc. Effectivement, les maladies auto-immunes résultent d’une réaction excessive du système immunitaire entraînant une attaque des tissus sains par les cellules immunitaires. Les patients sont souvent traités avec des médicaments immunosuppresseurs qui réduisent l’activité du système immunitaire afin de limiter les lésions tissulaires. Cependant, ces traitements augmentent le risque d’infections opportunistes virales, bactériennes ou fongiques7. Les corticostéroïdes sont couramment utilisés à long terme chez les patients atteints de maladies auto-immunes ou chez les receveurs de greffes d’organes qui sont également plus susceptibles de développer une kératite herpétique bilatérale. Les corticostéroïdes affaiblissent l’immunité en diminuant la production de cytokines, ce qui réduit notamment l’activation des lymphocytes et des macrophages8 Le HSV étant un virus opportuniste, les récidives sont donc plus fréquentes. La kératite herpétique peut également être plus difficile à traiter dans ces cas. Les patients infectés par le virus de l’immunodéficience humaine (VIH) présentent aussi un risque accru de kératite herpétique bilatérale tout comme certains patients atteints d’un cancer. L’âge est un autre facteur qui influence le risque de développer une atteinte bilatérale. En effet, de nombreux cas ont été signalés chez les enfants. Ce phénomène n’est pas encore bien compris, mais les infections par le HSV sont généralement plus graves chez les enfants et les lésions bilatérales sont plus fréquentes, tout comme les récidives11 Un dépistage et un traitement précoces sont importants, car cette population est plus susceptible de cicatrisation cornéenne et d’amblyopie9, 11. L’âge avancé est aussi associé à un risque accru d’infection bilatérale, car le système immunitaire s’affaiblit avec la sénilité6
Les patients atteints d’atopie présentent généralement une kératite herpétique oculaire plus grave et un risque accru d’atteinte bilatérale. L’atopie désigne la prédisposition génétique à développer des affections allergiques, de l’asthme et de l’eczéma. Le système immunitaire de ces patients réagit de manière excessive aux antigènes environnementaux qui n’affectent pas la majorité de la population. Un système immunitaire instable les rend plus vulnérables à la kératite herpétique11
Certains médicaments ophtalmiques, notamment les analogues de prostaglandines, ont été associés à un risque accru de réactivation de la kératite herpétique, possiblement via une augmentation de l’inflammation intraoculaire. La littérature ne fait pas de distinction entre les différentes marques d’analogues de prostaglandines existantes, suggérant qu’elles peuvent toutes présenter un risque de réactivation. Ces données sont controversées. Certains auteurs suggèrent que les réactivations seraient plutôt secondaires à la toxicité cornéenne liée à un usage à long terme de gouttes contenant des agents de conservation. L’utilisation d’analogues de prostaglandines n’est pas une contre-indication définitive chez les patients ayant des antécédents de HSV oculaire6, 10
Le diabète sucré s’est avéré être un facteur de risque pour le HSV oculaire, en particulier chez les patients présentant un mauvais contrôle glycémique. Les patients diabétiques peuvent avoir un système immunitaire affaibli qui les prédispose aux infections opportunistes11
Les chirurgies oculaires peuvent présenter un risque de réactivation du HSV ou de kératite bilatérale à HSV. Les chirurgies réfractives au laser (LASIK/PRK) sont associées à un faible taux de récidive. Seuls quelques cas ont été rapportés. En revanche, les chirurgies oculaires pénétrantes sont un facteur de risque connu. Le traumatisme cornéen et l’inflammation consécutive aux procédures, associés à l’administration postopératoire de corticostéroïdes, favorisent le développement d’infections virales opportunistes. Un traitement antiviral prophylactique par voie orale est recommandé pour les patients ayant des antécédents d’HSV11. Le crosslinking cornéen (CXL) est une procédure utilisant le rayonnement ultraviolet A pour stabiliser la progression d’ectasies cornéennes telle que le kératocône. Les UVA réduisent la fonction immunitaire en créant une réaction de stress et en déclenchant la sécrétion de protéines immunosuppressives telles que l’interleukine IL-10. Par conséquent, un traitement antiviral prophylactique est également recommandé6
Les infections des voies respiratoires supérieures et la fièvre ont également été associées à la réactivation de l’herpès simplex. De nombreux mécanismes sont impliqués, notamment le stress thermique et l’inflammation systémique. D’autres facteurs de stress tels que les rayons UV du soleil, le stress émotionnel et les menstruations sont également associés aux récidives de kératite herpétique6, 11, 12
La patiente dont il est question dans ce cas clinique ne présentait aucun facteur de risque spécifique de kératite herpétique bilatérale, à l’exception de symptômes grippaux et de fièvre, qui coïncidaient avec chaque récidive.
Traitement :
Les traitements actuels réduisent la réplication virale et diminuent le risque de complications, mais aucun traitement ne permet de guérir complètement une personne infectée. Une fois contracté, le virus de l’herpès simplex restera latent pendant toute la vie du patient. Les traitements oculaires varient en fonction des couches cornéennes touchées. En cas de kératite épithéliale, on peut prescrire des gouttes antivirales topiques (ganciclovir ou trifluridine) ou des médicaments antiviraux oraux (acyclovir, valacyclovir ou famciclovir). Le choix entre un traitement topique ou oral doit être adapté au patient. Les gouttes topiques sont à privilégier chez les patients souffrant d’insuffisance rénale, sous traitement immunosuppresseur, ainsi que chez les femmes enceintes ou qui allaitent. En revanche, les antiviraux oraux sont préférés chez les patients souffrant de maladies de surface oculaire, telles que la sécheresse oculaire, ou qui ont des difficultés à mettre des gouttes. Il est essentiel d’éviter les corticostéroïdes topiques, car ils ralentissent le système immunitaire, ce qui favorise la réplication du HSV. En revanche, en cas de kératite stromale, l’étude HEDS a prouvé que les corticostéroïdes topiques sont bénéfiques. On recommande une diminution progressive sur plusieurs semaines. L’étude HEDS suggère au moins 10 semaines de corticothérapie topique. Un traitement antiviral prophylactique topique ou oral devrait être ajouté, l’option privilégiée étant les antiviraux oraux. Le traitement de la kératite endothéliale est similaire à celui de la kératite stromale1, 11, 15. En cas de doute sur le diagnostic, compte tenu de la forte prévalence du HSV-1, l’ajout d’un médicament antiviral est recommandé chez les patients présentant une kératite suspecte.
Les épisodes récurrents de kératite herpétique sont associés à un risque accru de réactivations supplémentaires. L’étude HEDS a conclu que l’utilisation à long terme d’antiviraux oraux diminue les risques de récidives. Dans le cadre de cette étude, 400 mg d’acyclovir ont été administrés deux fois par jour aux patients pendant un an, ce qui a entraîné une réduction de 45 % des récidives. Il est important de garder en tête que dès l’arrêt du traitement, le risque revient à son niveau préthérapeutique. La prise d’antiviraux à long terme comporte peu de risques. Comme ils sont métabolisés par le foie et excrétés par les reins, il est important de vérifier la fonction hépatique et rénale une fois par an11, 15
Conformément à ces recommandations, lors de sa première visite, notre patiente a été traitée par antiviraux oraux. Le valacyclovir a été préféré à l’acyclovir en raison de sa meilleure biodisponibilité et de son schéma posologique moins demandant. Le valacyclovir a été progressivement réduit à mesure que l’état de la patiente s’améliorait. Lorsque l’épithélium s’est complètement refermé, des corticostéroïdes topiques ont été ajoutés afin de réduire la cicatrisation, puisqu’elle présentait une atteinte visuelle. En raison de ses antécédents de récidives rapprochées, un traitement prophylactique à long terme de valacyclovir a été instauré et aucune nouvelle récidive n’a été observée depuis.
BIBLIOGRAPHIE :
1. Bronner Aaron. (2017, March 15). Dendrites: Misdiagnosis Not Permitted. Review of cornea & contact lenses. https://www. reviewofcontactlenses.com/article/dendrites-misdiagnosisnot-permitted#:~:text=HSV%20keratitis%20is%20the%20 most%20frequent%20initial%20misdiagnosis%20of%20 Acanthameoba,ulcerated%20and%20may%20have%20 perineuritis
2. BC Center for Disease Control. Herpes: A Patient’s Guide. http://www.bccdc.ca/resource-gallery/Documents/ Educational%20Materials/STI/Herpes%20Patient%20Guide.pdf
3. Staff. (2007, August 15). Acanthamoeba Keratitis Often Mistaken for Herpes Simplex. Review of optometry. https://www.reviewofoptometry.com/article/acanthamoebakeratitis-often-mistaken-for-herpes-simplex
4. M Nijm, L., Feldman, B. H., Kozak, A., Chang, V., Doss, Mallika., Bunya, V. Y., Hossain, K., Vannadil, H., Gurnani, B., Allee, L. (2025, May 9). Herpes Simplex Epithelial Keratitis. American academy of ophtalmology. https://eyewiki.org/Herpes_ Simplex_Epithelial_Keratitis#:~:text=The%20differential%20 diagnoses%20of%20HSV,soft%20contact%20lens%20 overwear%2C%20microbial
5. Agence de la santé publique au Canada. (2011). Fiche Technique Santé-Sécurité : Agents Pathogènes – Herpes simplex virus. https://www.canada.ca/fr/sante-publique/services/biosecuritebiosurete-laboratoire/fiches-techniques-sante-securite-agentspathogenes-evaluation-risques/virus-herpes-simplex.html
6. Chaloulis, S. K., Mousteris, G., Tsaousis, K. T. (2022, June 7). Incidence and Risk Factors of Bilateral Herpetic Keratitis: 2022 Update. PubMed. https://pmc.ncbi.nlm.nih.gov/articles/ PMC9229676/
7. Cleveland Clinic. (2023, August 1). Immunosuppressants. Cleveland Clinic. https://my.clevelandclinic.org/health/ treatments/10418-immunosuppressants
Conclusion :
La kératite herpétique bilatérale est une affection rare causée par la réactivation du virus HSV latent dans les ganglions trigéminaux. Le HSV oculaire se manifeste généralement sous forme de blépharoconjonctivite ou de kératite unilatérale. Les patients immunodéprimés, atopiques ou atteints de maladies auto-immunes présentent un risque accru d’atteinte bilatérale. D’autres facteurs, tels que le stress émotionnel et la fièvre, constituent également des facteurs de risque de kératite herpétique. Le traitement de la kératite bilatérale est le même que celui de la kératite unilatérale. Il dépend des couches cornéennes affectées. La kératite épithéliale est causée par un virus actif qui se réplique dans l’épithélium cornéen et nécessite un traitement antiviral topique ou oral. Les corticostéroïdes doivent être évités dans un premier temps. En revanche, les kératites stromales et endothéliales sont à médiation immunitaire et nécessitent des corticostéroïdes en plus du traitement antiviral. Un traitement antiviral prophylactique oral à long terme est recommandé à faible dose si le patient présente de multiples récidives.
8. Yasir, M., Goyal, A., Sonthalia, S. (2023, July 3). Corticosteroid Adverse Effects. National Library of Medicine. https://www.ncbi. nlm.nih.gov/books/NBK531462/#:~:text=By%20altering%20 the%20cytokine%20production,neutrophils%2C%20 eosinophils%2C%20and%20basophils.
9. Vadoothker, S., Andrews, L., Jeng, B., Levin, M., (2018, September). The pediatric Infectious Disease Journal. (vol. 44, p. 949-951) https://journals.lww.com/pidj/ Fulltext/2018/09000/Management_of_Herpes_ Simplex_Virus_Keratitis_in.22.aspx?generateEpub= Article%7Cpidj:2018:09000:00022%7C10.1097/ inf.0000000000002114%7C
10. Shokoohi, S., Iovieno, A., Etminan, M., Yeung, S. Effect of topical anti-glaucoma drugs on the incidence of herpetic simplex keratitis. iovs. https://iovs.arvojournals.org/article. aspx?articleid=2742551
11. White, M. L., Chodosh, J. (2014). Herpes Simplex Virus Keratitis: A Treatment Guideline. Harvard Medical School. file:///Users/ rossanapopdoneva/Downloads/HSV%20Keratitis%20 Treatment%20Guideline%20Harvard.pdf
12. Suzich, J. B., Cliffe, A. R. (2018, September). Strength in diversity: Understanding the pathways to herpes simplex virus reactivation. ScienceDirect, 522, 81-91. https://www.sciencedirect.com/science/article/pii/ S0042682218302137#s0025
13. Kaye, K. M., (2023 December). Herpes Simplex Virus (HSV) Infections. MSD Manual. https://www.msdmanuals.com/home/ infections/herpesvirus-infections/herpes-simplex-virus-hsvinfections
14. Knickelbein, J. M., Bunya, V. Y., Woodward, M. A., Weissbart, S. B. (2025, January 10). Herpes Simplex Virus Stromal keratitis and Endotheliitis. American academy of ophtalmology. https://eyewiki.org/Herpes_Simplex_Virus_Stromal_Keratitis_ and_Endotheliitis
15. Burling, L. Asbell, P. A., Cohen, E. J., Tuli S. S. (2021, July 1). Key Cornea Trials: The Legacy of HEDS, the Promise of ZEDS. American academy of ophthalmology. https://www.aao.org/ eyenet/article/key-cornea-trials-legacy-of-heds-promise-ofzeds




PLUS DE PERFORMANCES
grâce à une composition chimique avancée, associée à une conception optimale de la lentille cornéenne¹, pour un confort inégalé*†‡²-4.

pour s’adapter avec plus de précision à pratiquement toutes les prescriptions et permettre d’ajuster davantage de patients5.
Sphérique Torique Multifocale


MyDayMD contribue à la rentabilité de votre pratique liée aux lentilles cornéennes6.
EN SAVOIR PLUS SUR MYDAY
* Comparé à DAILIES TOTAL1® Multifocal et ACUVUE® OASYS MAX 1-Day MULTIFOCAL. † Comparé à ACUVUE® OASYS 1-Day for ASTIGMATISM, PRECISION1® for ASTIGMATISM et DAILIES TOTAL1® for Astigmatism. ‡ Comparé à ACUVUE® OASYS MAX 1-Day, PRECISION1® et INFUSE® One-Day (É.-U.) / ULTRA® ONE DAY (hors É.-U.).
1. Données internes, CVI, 2024. 2. Données internes, CVI, 2021 et 2023. MyDay® multifocal comparé à DAILIES TOTAL1® Multifocal (n=59) et ACUVUE® OASYS MAX 1-Day MULTIFOCAL (n=56); aucune différence statistiquement significative (p>0,05) à la distribution, aux jours 6 et 13 lors de la pose et tout au long de la journée aux jours 6 et 13. 3. Données internes, CVI, 2017, 2021 et 2023. MyDay® toric comparé à ACUVUE® OASYS 1-Day for ASTIGMATISM (n=20), PRECISION1® for Astigmatism (n=47) et DAILIES TOTAL1® for Astigmatism (n=54); aucune différence statistiquement significative (p>0,05) à la distribution et après une semaine de port quotidien lors de la pose et du retrait. 4. Données internes, CVI, 2021 et 2023. MyDay® comparé à PRECISION1® (n=35 : distribution 9,1 vs 9,4 p=0,13; jour 5 8,2 vs 8,4 p=0,39), INFUSE® One-Day / ULTRA® One-Day (n=64 : distribution 9,3 vs 9,1 p=0,33; jour 5 8,3 vs 8,7 p=0,13), ACUVUE® OASYS MAX 1-Day (n=68 : distribution 9,3 vs 9,5 p=0,18; jour 6 8,8 vs 9,1 p=0,06). 5. Données internes, CVI, 2023. Basé sur les combinaisons d’options d’ordonnance disponibles à partir de sources publiées (sphère, cylindre, axe, addition) pour toutes les lentilles cornéennes souples jetables quotidiennes sphériques, toriques et multifocales de CVI, Johnson & Johnson Vision Care, Bausch + Lomb et Alcon aux États-Unis, juillet 2023. Les lentilles cosmétiques ne sont pas incluses. Les variantes multiples de courbure de base ne sont pas incluses. 6. Données internes, CVI, 2025. Rapports internes et estimations. n=6 066. Croissance de la rentabilité des cabinets lorsque le professionnel de la vue commence à adapter MyDay® en complément de clariti® 1 day. ©2026 CooperVision SA*16902


Dans le viseur : publications récentes en optométrie
Le monde de l’optométrie est en constante évolution. Portée par les avancées technologiques, la recherche scientifique et l’évolution des besoins des patients, la profession se transforme rapidement. De nouvelles approches en matière de dépistage, de traitement et de gestion des troubles visuels voient régulièrement le jour, tandis que les innovations en imagerie, en lentilles ophtalmiques et en outils numériques redéfinissent la pratique clinique au quotidien.
Dans ce contexte dynamique, il est essentiel de rester à l’affût des changements qui façonnent la profession, qu’ils soient d’ordre scientifique, technologique, réglementaire ou économique. S’informer permet non seulement d’anticiper les tendances, mais aussi d’offrir des soins toujours plus adaptés et performants à sa clientèle. Voici 9 nouvelles qui ont retenu notre attention et qui pourraient avoir un impact concret sur votre pratique et sur l’avenir de l’optométrie.
Ce texte a été produit avec l’assistance de l’intelligence artificielle.
Thérapie à DEL non invasive pour le traitement précoce de la cataracte : une perspective pour la pratique optométrique1
Une thérapie à DEL non invasive pourrait cibler la cataracte à un stade précoce, avec une innocuité à long terme démontrée. Il s’agit d’une approche clinique innovante qui vise à intervenir avant l'opération, sans laser ni opération invasive.
Une nouvelle approche thérapeutique non invasive utilisant une lumière DEL à faible intensité est actuellement à l’étude pour la prise en charge de la cataracte à un stade précoce. Cette technologie vise à combler l’écart clinique entre la simple surveillance et la référence chirurgicale, en proposant une intervention potentielle chez des patients présentant des changements visuels fonctionnels, mais ne répondant pas encore aux critères d’une opération de la cataracte.
Le traitement repose sur l’administration, en clinique, de longueurs d’onde spécifiques de lumière DEL dirigées vers le cristallin. Il ne s’agit pas d’un laser et la procédure n’implique aucune intervention invasive ni modification structurelle du cristallin. Son mode d’administration, compatible avec un contexte de soins de première ligne, en fait une approche particulièrement pertinente du point de vue de l’optométrie. Après les essais cliniques complétés en 2025, on a procédé à un suivi longitudinal visant à évaluer l’innocuité à long terme du traitement.
Les patients ont été suivis pendant une durée moyenne d’environ 20 mois, jusqu’à 36 mois pour certains participants. Durant cette période, on n’a rapporté aucun événement indésirable et la fonction visuelle est demeurée stable, ce qui suggère un profil d’innocuité favorable, élément clé pour toute intervention envisagée à un stade précoce de la maladie.
Les paramètres détaillés du protocole de traitement, notamment le nombre de séances et leur durée, n’ont pas encore été publiés et devraient être communiqués ultérieurement dans des publications scientifiques. Néanmoins, selon les données disponibles, il serait possible d’avoir recours à une approche non chirurgicale intégrée à un parcours de soins longitudinal.
Pour les optométristes, cette technologie pourrait représenter une option supplémentaire entre la surveillance clinique et la référence en ophtalmologie, avec le potentiel de retarder la progression fonctionnelle de la cataracte et de renforcer le rôle de l’optométrie dans la prise en charge continue de cette pathologie hautement prévalente.
Deseyne EDOF : une nouvelle option en lentilles cornéennes pour la presbytie2
Première lentille cornéenne journalière EDOF approuvée pour la presbytie aux États-Unis. Une solution de rechange non multifocale offrant une vision continue de près à loin, avec une adaptation minimale.
Une nouvelle lentille cornéenne journalière destinée à la correction de la presbytie utilisant une technologie Extended Depth of Focus (EDOF) a récemment obtenu une autorisation de mise en marché aux États-Unis. Il s’agit de la première lentille souple à port quotidien à intégrer une conception optique EDOF, une technologie jusqu’ici réservée aux lentilles intraoculaires, élargissant ainsi les options non chirurgicales offertes aux patients presbytes.
La lentille Deseyne EDOF repose sur une conception optique brevetée intégrant une zone centrale hyperréfractive unique, conçue pour rediriger la lumière de manière contrôlée afin de créer une profondeur de champ continue. Contrairement aux lentilles multifocales traditionnelles, cette approche ne repose pas sur des zones optiques multiples ni sur la suppression simultanée de différentes images. Elle vise plutôt à offrir une vision fonctionnelle fluide de près, intermédiaire et de loin, tout en réduisant les compromis visuels et la période d’adaptation souvent associée aux conceptions multifocales.
Sur le plan des matériaux, la lentille intègre une technologie combinant l’acide hyaluronique et des polysaccharides issus de graines de tamarin, formant un biocopolymère naturel dont les propriétés s’apparentent à celles des larmes naturelles. Ce complexe est conçu pour être libéré de façon dynamique en réponse à des facteurs physiologiques tels que la température corporelle, le clignement et la pression des paupières, contribuant ainsi au maintien de l’hydratation, du confort et de la stabilité visuelle tout au long de la journée.
Les données cliniques sur lesquelles s’appuie l’approbation réglementaire démontrent des améliorations cliniquement significatives de l’acuité visuelle en vision de près et intermédiaire, sans signalement d’événements indésirables. La lentille s’est également distinguée par une acceptation rapide chez les patients et un taux de réussite élevé à l’adaptation, des éléments particulièrement pertinents pour la pratique optométrique quotidienne.
Du point de vue clinique, la Deseyne EDOF représente une nouvelle option intermédiaire entre les lentilles multifocales et la monovision. Elle pourrait simplifier le processus d’adaptation, améliorer l’expérience visuelle des patients presbytes et enrichir l’arsenal thérapeutique des optométristes dans la prise en charge de cette population croissante.
Resvératrol et rétinopathie diabétique précoce : une piste thérapeutique émergente3
Le resvératrol pourrait cibler les mécanismes précoces de la rétinopathie diabétique, avant l’apparition des lésions vasculaires. Une approche potentielle axée sur la neuroprotection et l’inflammation, ce qui est complémentaire aux traitements actuels.
La rétinopathie diabétique (RD) demeure une cause majeure de perte visuelle, et les traitements actuellement disponibles, tels que les injections antiVEGF et la photocoagulation au laser, sont principalement indiqués à des stades avancés de la maladie. Une analyse récente de la littérature met en lumière le resvératrol, un polyphénol aux propriétés antioxydantes et antiinflammatoires, comme candidat potentiel pour une intervention à un stade précoce de la RD, en ciblant des mécanismes pathogéniques en amont des atteintes microvasculaires cliniquement visibles.
Le resvératrol est une molécule d’origine végétale, abondante notamment dans le raisin, reconnue pour ses effets protecteurs dans divers contextes métaboliques et cardiovasculaires. Les données précliniques analysées suggèrent que cette molécule exerce des effets bénéfiques sur plusieurs processus clés impliqués dans la pathogenèse précoce de la RD, incluant la réduction du stress oxydatif, la préservation de la fonction mitochondriale, la modulation de l’inflammation rétinienne et la protection des neurones rétiniens. Un élément central de son action serait l’activation de la voie SIRT1, associée à des effets antiapoptotiques et neuroprotecteurs.
Un aspect novateur de cette synthèse réside dans l’analyse intégrée des effets du resvératrol sur les mécanismes épigénétiques et sur l’activation des microglies rétiniennes, qui jouent un rôle clé dans l’amplification de l’inflammation chronique observée dans la RD. Les études évaluées démontrent de façon cohérente une atténuation des phénotypes microgliaux proinflammatoires, suggérant un basculement vers un environnement rétinien plus protecteur à un stade précoce de la maladie.
Il est toutefois important de souligner que les données disponibles proviennent majoritairement d’études précliniques et de modèles animaux, et que les données cliniques humaines demeurent limitées pour l’instant. Les auteurs soulignent la nécessité d’essais cliniques rigoureux afin de déterminer les doses optimales, la durée de traitement et la pertinence clinique réelle du resvératrol dans la prévention ou le ralentissement de la progression de la RD.
Pour les optométristes, ces résultats soulignent l’intérêt croissant pour des stratégies neuroprotectrices et antiinflammatoires précoces, susceptibles de s’intégrer à une prise en charge des patients diabétiques. Le resvératrol ne constitue pas à l’heure actuelle une recommandation thérapeutique, mais représente une piste de recherche prometteuse susceptible, à terme, de compléter les approches actuelles centrées sur les complications vasculaires tardives de la rétinopathie diabétique.
La position de sommeil et la pression intraoculaire : un facteur modifiable en glaucome?4
Dormir avec plusieurs oreillers pourrait augmenter la pression intraoculaire chez les patients glaucomateux. Un simple changement de posture nocturne pourrait influencer la progression du glaucome.
Une étude observationnelle récente suggère que la position de la tête et du cou pendant le sommeil pourrait influencer la pression intraoculaire (PIO) nocturne chez les patients atteints de glaucome. Les chercheurs se sont intéressés à l’effet d’une élévation de la tête à l’aide de plusieurs oreillers, une habitude courante chez de nombreux patients, mais rarement abordée en pratique clinique.
L’étude a porté sur 144 adultes atteints de différentes formes de glaucome, incluant le glaucome à tension normale, l’hypertension oculaire et le glaucome primaire à angle ouvert. Les participants ont bénéficié d’un monitorage de la PIO sur 24 heures, avec des mesures effectuées toutes les deux heures en position assise et couchée. Les comparaisons ont été réalisées entre une position couchée à plat et une position avec la tête surélevée d’environ 20 à 35 degrés à l’aide de deux oreillers standards.
Les résultats montrent que près de deux tiers des participants (67 %) ont présenté une augmentation mesurable de la PIO lors du passage d’une position couchée à plat à une position avec oreillers. L’élévation moyenne observée était d’environ 1,6 mmHg, accompagnée d’une augmentation de la fluctuation diurne de la PIO. De plus, la pression de perfusion oculaire (PPO), un indicateur indirect de l’apport sanguin au nerf optique, était significativement plus basse lorsque la tête était surélevée, ce qui pourrait avoir des implications sur la santé du nerf optique.
Des analyses secondaires ont révélé que les patients plus jeunes et ceux atteints de glaucome primaire à angle ouvert étaient plus susceptibles de présenter des augmentations de PIO liées à la posture. Afin d’explorer un mécanisme potentiel, les chercheurs ont également évalué la dynamique veineuse cervicale chez des volontaires sains. Les examens ont montré que l’élévation de la tête à l’aide d’oreillers pouvait rétrécir la lumière de la veine jugulaire, suggérant une entrave au drainage veineux et, par conséquent, à l’écoulement de l’humeur aqueuse.
Les auteurs soulignent que, bien que les résultats soient préliminaires et issus d’une étude observationnelle, la posture de sommeil pourrait représenter un facteur modifiable simple et à faible risque à considérer dans la prise en charge globale du glaucome. Ils recommandent toutefois des études longitudinales supplémentaires avant d’émettre des recommandations cliniques formelles.
Yuvezzi : une nouvelle génération de gouttes pour la presbytie5
La première goutte bifonctionnelle approuvée pourrait redéfinir la correction pharmacologique de la presbytie. Yuvezzi s’ajoute à un marché en évolution et force une réflexion sur la notion de bon patient au bon moment.
La FDA a récemment approuvé YuvezziMC, la première et seule goutte ophtalmique à double agent indiquée pour le traitement de la presbytie chez l’adulte. Cette nouvelle option marque une évolution importante dans un domaine jusque-là dominé par des agents miotiques à molécule unique, en combinant carbachol (2,75 %) et brimonidine tartrate (0,1 %) dans une formulation quotidienne unique.
Sur le plan pharmacologique, Yuvezzi vise à optimiser l’« effet trou sténopéique » par deux mécanismes complémentaires : la contraction du sphincter irien induite par le carbachol et l’inhibition de la contraction du muscle dilatateur de l’iris par la brimonidine. Cette combinaison permet d’obtenir un myosis fonctionnel plus durable, tout en cherchant à réduire certains effets indésirables typiquement associés aux agents miotiques seuls (vision floue de loin, gêne visuelle en faible luminosité, diminution de la sensibilité au contraste, céphalées frontales ou périorbitaires). L’effet clinique débute environ 30 minutes après l’instillation et se maintient jusqu’à 8 à 10 heures avec une seule goutte quotidienne, sans perte cliniquement significative d’AV de loin.
L’approbation repose sur deux essais cliniques de phase 3 (BRIOI et BRIOII), incluant plus de 800 patients, la plus longue étude d’innocuité menée à ce jour pour une goutte contre la presbytie. Les résultats démontrent une amélioration significative de trois lignes ou plus en AV non corrigée de près, tout en maintenant l’AV de loin. Le profil de tolérance est jugé favorable, avec des effets indésirables principalement légers (céphalées, inconfort oculaire transitoire) et un faible taux d’hyperémie comparativement au carbachol seul.
Du point de vue pratique, Yuvezzi s’inscrit dans un marché américain déjà occupé par d’autres gouttes contre la presbytie, notamment Vuity® (pilocarpine 1,25 %, AbbVie), Qlosi® (pilocarpine 0,4 %, Orasis Pharmaceuticals) et Vizz® (aceclidine 1,44 %, Lenz Therapeutics). Yuvezzi propose une durée d’action plus longue et potentiellement mieux tolérée, ce qui pourrait élargir le profil des patients candidats à une correction pharmacologique.
Pour les optométristes québécois, bien que Yuvezzi ne soit pas encore disponible au Canada, son approbation américaine souligne une tendance claire vers la personnalisation et la diversification des traitements non optiques de la presbytie. Cela renforce la nécessité d’une approche centrée sur le patient, tenant compte des exigences visuelles quotidiennes, de la tolérance aux effets miotiques et des attentes réalistes face à ces traitements.
Nonperfusion capillaire rétinienne et rétinopathie diabétique non proliférante (RDNP) légère à modérée : un signal précoce à ne pas négliger6
La nonperfusion capillaire progresse dès les stades précoces de la RD, bien avant les complications prolifératives. L’OCTA pourrait devenir un outil clé pour stratifier le risque de progression de la RDNP.
L’identification précoce des marqueurs de progression de la rétinopathie diabétique (RD) demeure un enjeu central en pratique optométrique. Une étude longitudinale récente démontre que la nonperfusion capillaire rétinienne progresse de façon mesurable dès les stades légers à modérés de la RD non proliférante (RDNP), soulignant l’importance d’une surveillance plus fine de la microvascularisation, audelà de la classification clinique traditionnelle.
Cette étude observationnelle longitudinale multicentrique européenne (CHART) a suivi 202 yeux de 155 patients atteints de diabète de type 2, présentant des stades de RDNP allant de légère à sévère. Les participants ont été évalués à l’aide de photographies couleur ETDRS à sept champs, d’OCT structurel et d’OCTangiographie (OCTA) au départ, puis à trois, six et douze mois. Cette approche multimodale a permis de quantifier les taux de progression de la nonperfusion capillaire.
Les résultats montrent que les yeux classés ETDRS 35 et 43 (RDNP légère à modérée) présentent une augmentation significative de la nonperfusion capillaire sur une période de un an, principalement mise en évidence par une diminution de la densité vasculaire et de la densité de perfusion au niveau du plexus capillaire superficiel à l’OCTA. À l’inverse, dans les stades plus avancés de RDNP (ETDRS 47 et 53), la nonperfusion tend à se stabiliser, avec l’apparition d’un profil d’hyperperfusion compensatoire, associé à une augmentation des microanévrismes et au développement d’anomalies microvasculaires intrarétiniennes (AMIR).
Un élément cliniquement pertinent de cette étude est la démonstration que la mesure des taux de changement, obtenue à partir d’au moins deux examens OCTA espacés de six mois, permet de détecter la progression microvasculaire de manière plus fiable que des évaluations isolées. De plus, certaines altérations structurelles, telles que l’amincissement des couches ganglionnaires et des changements de la zone avasculaire fovéolaire, étaient corrélées à une baisse de l’AV, suggérant un lien fonctionnel avec la nonperfusion capillaire.
Pour les optométristes québécois, ces données renforcent l’idée que l’OCTA pourrait jouer un rôle croissant dans la classification du risque de progression, la gestion des suivis et l’identification précoce des patients susceptibles de bénéficier d’une référence ou d’une intervention plus rapprochée.
Tirzépatide et rétinopathie diabétique : un risque limité à court terme?7
Le tirzépatide ne semble pas aggraver la rétinopathie diabétique durant la première année de traitement. Un élément important pour un médicament de plus en plus utilisé en diabète et en gestion du poids.
L’utilisation croissante du tirzépatide, un agoniste double des récepteurs GIP et GLP1, soulève des questions quant à son impact potentiel sur la rétinopathie diabétique (RD), notamment en raison des inquiétudes associées à une amélioration de la glycémie rapide, connue pour être liée à une aggravation transitoire de la RD avec certaines thérapies. Une étude observationnelle récente suggère toutefois que le tirzépatide est peu susceptible d’exacerber la RD au cours de la première année de traitement.
Dans cette étude de cohorte multicentrique, on a comparé des patients diabétiques traités par tirzépatide à des patients traités par des interventions de type hygiène de vie seule. Les analyses ont porté sur l’apparition de nouveaux diagnostics de RD, la progression vers des stades plus sévères et le recours à des interventions ophtalmiques telles que les injections intravitréennes d’anti-VEGF ou la photocoagulation panrétinienne. Après ajustement pour de multiples variables, l’introduction du tirzépatide n’a pas été associée à une augmentation du risque de RD, mais plutôt à une réduction du risque relatif de diagnostic de RD, avec un rapport de risque d’environ 0,74 comparativement au groupe témoin.
En ce qui concerne la progression de la RD et les complications nécessitant une intervention, les résultats vont dans le même sens. Le traitement par tirzépatide a été associé à un risque relatif réduit d’événements liés à la RD, incluant la progression et le recours à des procédures ophtalmiques (RR entre 0,65 et 0,80). Ces données suggèrent non seulement une absence de signal d’aggravation, mais également une tendance protectrice durant la première année de traitement.
Pour les optométristes québécois, ces résultats sont particulièrement pertinents dans un contexte où le tirzépatide est de plus en plus prescrit chez des patients qui ne présente pas de RD ou qui présentent une RD légère. Bien que la prudence demeure indiquée chez les patients avec une RD préexistante avancée ou une baisse rapide de l’HbA1c, les données actuelles pointent vers un effet rassurant à court terme.
SLT unilatérale et baisse de la PIO de l’œil controlatéral : un effet réel à considérer ?8
La SLT unilatérale peut entraîner une baisse mesurable de la pression intraoculaire dans l’œil non traité. Un phénomène à connaître pour interpréter le suivi post SLT en pratique clinique.
La trabéculoplastie sélective au laser (SLT) est largement utilisée dans la prise en charge du glaucome à angle ouvert et de l’hypertension oculaire. Toutefois, l’existence d’un effet controlatéral, soit une diminution de la pression intraoculaire (PIO) dans l’œil non traité après une SLT unilatérale, demeure une question souvent soulevée. Une revue systématique et méta-analyse récente apporte des données quantitatives sur ce phénomène.
Les auteurs ont analysé neuf études (incluant des essais randomisés et des études observationnelles), totalisant 478 yeux, portant sur des patients atteints de glaucome primaire à angle ouvert ou d’hypertension oculaire ayant reçu une SLT unilatérale. Les résultats montrent une baisse moyenne significative de la PIO de l’œil controlatéral de 1,85 mm Hg (IC 95 % : 1,23–2,47) entre 3 et 6 mois après le traitement. Cette réduction est observée tant après une SLT à 180° qu’à 360°, sans différence statistiquement significative entre les deux approches.
Une analyse de corrélation a également démontré une corrélation modérée positive entre la réduction de la PIO dans l’œil traité et celle observée dans l’œil controlatéral (coefficient de corrélation de Pearson regroupé : R = 0,65). Ce résultat suggère un mécanisme systémique ou neurohumoral sous-jacent, plutôt qu’un simple artefact de mesure ou une variabilité physiologique.
Sur le plan clinique, ces données sont importantes pour l’interprétation du suivi post SLT. Pour les optométristes québécois impliqués dans le suivi du glaucome en collaboration avec l’ophtalmologie, la reconnaissance de cet effet controlatéral permet une meilleure compréhension des réponses au traitement et une meilleure planification des étapes thérapeutiques ultérieures.
Prise en charge du syndrome de Charles Bonnet en soins visuels courants : structurer l’approche clinique9
Les hallucinations visuelles chez les patients atteints de basse vision sont plus fréquentes qu’on le pense. Une approche structurée peut transformer l’anxiété liée au syndrome de Charles Bonnet en un diagnostic rassurant. Le syndrome de Charles Bonnet (SCB) est caractérisé par des hallucinations visuelles chez des personnes présentant une déficience visuelle, en l’absence de trouble psychiatrique ou cognitif. Bien que fréquent, ce syndrome demeure sous reconnu et rarement abordé spontanément en consultation, souvent en raison de la crainte des patients d’être perçus comme atteints d’un trouble mental. Un article récent propose un cadre clinique structuré visant à faciliter l’identification, la discussion et la prise en charge du SCB dans les services de soins visuels de routine.
Les auteurs rappellent que le SCB peut survenir dans une large gamme de pathologies oculaires associées à une perte visuelle, incluant la dégénérescence maculaire, le glaucome, les neuropathies optiques et les maladies rétiniennes. Le mécanisme sousjacent le plus probable repose sur une hyperexcitabilité du cortex visuel secondaire à une réduction des afférences visuelles, un phénomène de « libération corticale ». Le risque augmente généralement avec la sévérité de la perte visuelle, mais le SCB peut également se manifester chez des patients dont l’acuité visuelle est relativement préservée.
Sur le plan épidémiologique, jusqu’à 20 % des patients suivis en services de basse vision présenteraient des symptômes compatibles avec le SCB à un moment donné de leur parcours visuel. Pour une majorité de patients, le simple fait de comprendre que ces hallucinations sont une conséquence reconnue et non psychiatrique de la perte visuelle entraîne une réduction marquée de l’anxiété. Toutefois, environ un tiers des patients vivent une forme dite « à impact négatif », associée à une détresse émotionnelle, une peur persistante et une diminution de la qualité de vie, nécessitant une prise en charge plus proactive.
L’article souligne que, bien que certains outils validés d’évaluation des hallucinations existent, leur utilisation systématique est peu réaliste en clinique. Les auteurs proposent donc un parcours simplifié, centré sur le dépistage actif par des questions normalisantes, l’exclusion de diagnostics différentiels (déclin cognitif, psychose, effets médicamenteux), l’éducation du patient et des stratégies non pharmacologiques pour réduire la fréquence ou l’intensité des symptômes. Cette approche vise à intégrer la prise en charge du SCB dans la pratique quotidienne, sans alourdir le déroulement des consultations.
Pour les optométristes québécois, ce cadre clinique met en lumière l’importance du rôle de première ligne dans l’identification et l’accompagnement des patients atteints de SCB. Une discussion ouverte et structurée permet non seulement de réduire la stigmatisation, mais aussi d’améliorer l’adhésion aux soins visuels et le bien-être global des patients vivant avec une perte de vision.
1. https://www.ophthalmologytimes.com/view/ noninvasive-led-light-therapy-shows-long-termsafety-in-early-cataract-clinical-follow-up?utm_ content=367927147&utm_medium=social&utm_ source=linkedin&hss_channel=lcp-18249135
2. https://www.optometrytimes.com/view/deseyne-edofdaily-contact-lenses-first-of-its-kind-approved-by-us-fda
3. Harley, O., Amelia, Y.S., Gustianty, E. et al. Resveratrol as a multitarget modulator in diabetic retinopathy: a systematic review of in vitro and in vivo studies. BMC Ophthalmol 26, 55 (2026). https://doi.org/10.1186/s12886-026-04623-0
4. Liu T, Hu M, Liu X, et al. Association of high-pillow sleeping posture with intraocular pressure in patients with glaucoma, British Journal of Ophthalmology Published Online First: 27 January 2026. doi: 10.1136/bjo-2025-328037
5. https://eyewire.news/news/fda-approves-yuvezzi-first-dualagent-eye-drop-for-presbyopia?c4src=article:infinite-scroll
6. Inês Pereira Marques, Débora Reste-Ferreira, Torcato Santos, Luís Mendes, Ana Cláudia Rocha, Francesco Bandello, Mariacristina Parravano, Leonardo Mastropasqua, Catherine Creuzot-Garcher, Sérgio Leal, Fabio Baschiera, José Cunha-Vaz; One-Year Progression of Capillary Nonperfusion in Nonproliferative Diabetic Retinopathy Using Noninvasive Imaging: The CHART Study. Trans. Vis. Sci. Tech. 2026;15(1):26. https://doi.org/10.1167/tvst.15.1.26.
7. Tirzepatide and Reduced Risk of Diabetic Retinopathy and Related Complications: A Multicenter U.S. Cohort Study, Shah, Jaffer et al. Ophthalmology, Volume 0, Issue 0
8. Wong, N.S.Q., Jin, E., Goh, C.X.Y. et al. The effect of selective laser trabeculoplasty on the intraocular pressure of the contralateral eye – a systematic review and metaanalysis. Eye (2026). https://doi.org/10.1038/s41433-025-04222-1
9. Jones, L., Ffytche, D.H. & Moosajee, M. Management of Charles Bonnet syndrome in routine eye care services. Eye (2026). https://doi.org/10.1038/s41433-02504215-0
PHOTO MYSTÈRE
Quel serait votre diagnostic ? Réponse en page 38

Podcast - Écoute voir
À ne pas manquer dans nos prochains podcasts ��
Sécheresse oculaire : des optométristes partagent leurs modèles gagnants.
Gestion de patrimoine : incorporation, retraite et meilleures pratiques pour optométristes d’aujourd’hui et de demain.


À l’occasion du mois de la santé visuelle, en mai, le CPRO prépare une promotion spéciale pour vous soutenir dans le développement de vos pratiques et la mise en valeur de la santé visuelle auprès de votre clientèle
D’autres détails suivront sous peu sur la page d’accueil du portail du CPRO.

centre-de-perfectionnement-et-de-référence-en-optométrie

Par
la
docteure Emanuelle Bédard
Optométriste, M.Sc
Une femme de 56 ans atteinte d’une maculopathie de Best bilatérale se présente pour un examen visuel régulier. Sa dernière évaluation remonte à plus de cinq ans. Elle ne conduit pas et effectue ses déplacements à pied ou en transport en commun. Sa principale plainte concerne des difficultés lors de la marche : elle trébuche fréquemment, éprouve des problèmes à percevoir les dénivelés et craint de tomber. Elle mentionne également avoir du mal à analyser les feux de circulation (feux pour piéton), particulièrement sur les grands boulevards à plusieurs voies.

Sur le plan professionnel, elle travaille avec un écran externe positionné à environ 50 cm. Elle ne dispose d’aucun aménagement visuel spécifique, son environnement de travail étant constitué de postes partagés. Elle rapporte des difficultés à lire les commentaires du clavardage lors de réunions en visioconférence et doit souvent demander à ses collègues de lui lire le contenu. Une évaluation avait été réalisée à l’INLB il y a plus de dix ans, mais sa vision était alors jugée supérieure aux critères d’admission pour bénéficier d’aides techniques.
Voici les détails de l’examen:
Lunettes actuelles : + 3.00 sph OU add +3.50 bifocal ST-28.
AV VL : OD 4/182 (6/273) échelle Feinbloom (DVI). OS 6/24 NATS Snellen.
AV VP : 1,25M @ 30 cm. Lecture fluide 45-60 mots/min.
MAV : OD Balance. OS +3,50/-0,75x086.
La réfraction a été faite en lunettes d’essai après une tentative échouée au visiomètre. L’oeil droit n’est pas sensible avec des flips +/- 3.00D ce qui est attendu avec une acuité de 6/273. Il a été convenu de conserver des lentilles bifocales compte-tenu des difficultés à percevoir les dénivelés et d’un échec passé à utiliser des lentilles progressives.
À sa demande, la puissance de l’addition (add +3.50) a été conservée bien qu’une addition plus faible (+2.00) aurait mieux correspondu à la distance de travail (écrans à 50 cm).
Perle clinique
Il est plus approprié de faire les réfractions en lunettes d’essai en présence de maculopathies. Cette approche favorise l’utilisation de la fixation excentrique. L’utilisation d’une cible visuelle générique (visage, paysage…) plutôt que des lettres réduit l’impact du scotome central sur la réfraction. En effet, si une lettre est masquée par le scotome au moment de la présentation d’une lentille, le patient pourrait penser, à tort, que cette lentille embrouille la vision alors qu’il s’agit plutôt d’un mauvais contrôle de la fixation visuelle.
Avec le recul, une approche à deux lunettes aurait pu être envisagée : Une paire de lunettes simple vision de loin pour les déplacements; Une paire dégressive ou bifocale adaptée au travail de bureau, avec une addition intermédiaire de +2.00 dans la partie supérieure de la lentille et une addition de +3.50 dans la zone inférieure pour la lecture.

Aucun essai de loupe n’a été tenté à cet examen visuel puisque la dame ne rapportait aucune gêne lors des activités de près. Une section ultérieure abordera la méthode de détermination de la puissance approximative d’une aide optique au près.

Discussion
La patiente est actuellement admissible aux centres de réadaptation par son acuité visuelle (<6/18 avec condition dégénérative). Une discussion a été amorcée sur les difficultés de déplacement qui pourraient être compensées avec un télescope de faible puissance (2x à 4x) afin de visualiser les panneaux de signalisation ainsi que les numéros d’autobus. Un spécialiste en orientation et mobilité (SOM) pourrait aider aux déplacements sécuritaires, particulièrement aux abords de grosses artères. Le spécialiste en réadaptation en déficience visuelle (SRDV) s’occuperait, quant à lui, de l’adaptation d’un poste de travail et de techniques pour faciliter les activités de la vie quotidienne.
Nous avons également discuté de la possibilité de s’identifier comme personne malvoyante auprès de ses collègues de travail. La patiente rapportait des situations de collègues qui la saluaient de loin, mais qu’elle ne reconnaissait pas. Il y a plusieurs raisons pour lesquelles une personne malvoyante préfère ne pas s’identifier comme tel: le regard d’autrui, la perception d’être capable de fonctionner malgré la déficience, la peur du jugement, la peur de perdre son emploi, etc.
Au cours des deux dernières semaines, à quelle fréquence avez-vous été dérangé par l’un ou l’autre des problèmes suivants?
1. Peu d’intérêt ou de plaisir à faire des choses
2. Se sentir démoralisé, déprimé ou désespéré

L’examen du fond d’oeil révèle une maculopathie centrale OU de stade V (atrophique) (Figures 1 et 2). À l’OCT il y a accumulation de liquide entre l’EPR et les photorécepteurs en plus d’une zone atrophiée centrale OD et de changement à l’EPR OS (Figures 3 et 4).

La déficience visuelle amène son lot de difficultés et d’incompréhensions par les pairs et la condition visuelle est largement associée à des symptômes dépressifs, dans une proportion de 20 à 50%. C’est pourquoi les symptômes dépressifs ont été abordés avec la patiente lors de l’examen. À ce sujet, il existe un questionnaire très rapide, le PHQ-2 (Tableau 1) qui permet de dépister les symptômes dépressifs en 2 questions. Un score de 3 ou plus suggère une dépression et devrait pousser l’optométriste à référer vers le médecin traitant, une ressource psychosociale, le CLSC ou le 811. N’oublions pas la ligne 1-866-APPELLE (1-866-277-3553) pour la prévention du suicide. Les centres de réadaptation visuels offrent, quant à eux, des groupes de soutien et ont parfois des intervenants psychosociaux disponibles pour les usagers.
Jamais (0)
Plusieurs jours (1)
Plus de la moitié des jours (2)
Presque tous les jours (3)
Tableau 1 : Patient Health Questionnaire-2 (PHQ-2). Disponibles en plusieurs langues à www.phqscreeners.com
En résumé, cet examen a été fait lors d’un examen en bureau privé et non en centre de réadaptation. Aucun élément de ce cas est hors de la portée d’un optométriste régulier. Même si l’optométriste ne fournit aucune aide visuelle, son rôle n’est pas moins crucial pour donner des conseils et faire le tremplin vers d’autres outils tels les centres de réadaptation et les ressources psychologiques. Amorcer les discussion sur les difficultés émotionnelles et fonctionnelles et donner espoir qu’il y a des outils pour pallier aux défis reliés à une déficience visuelle sont des bouffées d’air frais pour ces personnes qui, pour la plupart, vivent avec beaucoup de détresse.
Perles cliniques
D’un côté plus technique, voici une règle simplifiée afin d’évaluer la puissance des loupes nécessaires pour débuter les essais d’aides optiques.
Supposons une capacité de lecture de 1,25M à 30 cm. Si l’on vise une lecture de 0,5M avec la même fluidité, il est nécessaire de fournir un grossissement de 2,5x. Il est possible d’obtenir un grossissement en rapprochant le texte à une distance de 12 cm (voir le calcul dans l’encadré). Or, 12 cm (0,12m) est équivalent à une valeur dioptrie de 8,3D (1/0,12). La première loupe ou lunettes microscopiques à essayer seront donc de 8D. Il s’agit évidemment d’une estimation grossière, mais qui permet d’avoir une valeur de départ. Pas besoin de calculs savants, une simple règle de 3 suffit !
Lecture actuelle But visé 1,25 M = 0,5 M 30 cm x cm x = 12 cm (8,3D)
Avec les loupes, il est utile de se rappeler que plus les lentilles sont puissantes, plus le diamètre de la lentille diminue. C’est pourquoi une loupe trop forte n’est pas utile. Bien que le patient voit plus gros, il n’est possible que de voir quelques lettres à la fois de sorte que la vitesse de lecture chute dramatiquement. Pour cette raison, il est rare d’utiliser des loupes plus puissantes que 24D. Au-delà de cette puissance, il est préférable d’orienter vers une télévisionneuse (portative ou à plateau) ou une Peak Lupe (10-15x) qui offriront un champ visuel plus grand.
Une autre astuce, avec les loupes à main, est de rapprocher la loupe des yeux. Le champ visuel en sera optimisé et la lecture sera plus fluide. À noter qu’il y a souvent une résistance de la part des patients qui sont bien ancrés dans leurs habitudes de lecture et qui refusent de coller les livres plus près de leur nez. Le choix de l’aide optique dépendra de la nécessité d’avoir les mains libres, de la mobilité, de la distance à laquelle les activités ont lieu, etc. N’oublions pas l’ajout d’un éclairage d’appoint dirigée vers la tâche (et pas dans les yeux!). Ce petit ajout peut faire toute la différence, surtout pour les gens qui ont une atteinte à la sensibilité aux contrastes. Le choix de l’intensité lumineuse et de la couleur dépendra du niveau d’éblouissement, de la présence de cataracte et des préférences de l’utilisateur.
Les rétinopathies de type Best sont des conditions génétiques dominantes à pénétrance variable touchant une personne sur 10 000. La maladie engendre la dysfonction de l’épithélium pigmentaire rétinien (EPR) qui entraîne une accumulation de liquide entre l’EPR et les photorécepteurs. La présence de liquide ralentit la phagocytose des photorécepteurs, qui provoquera alors une accumulation de substances toxiques entre l’EPR et les photorécepteurs. Avec les années, la dégénérescence progressive des cellules rétiniennes culminera à l’atrophie maculaire.
On retrouve 6 phases dans la maladie de Best (Tableau 2)
Apparence clinique AV
Stade I (Prévitelliforme)
Stade II (Vitelliforme)
Stade III (Pseudohypopion)
Stade IV (Vitelliruptive)
Stade V (atrophique)
Stade VI (CNV)
Changements subtils de l’EPR 6/6
Apparence classique de « jaune d’oeuf »
Presque normal
Dépôt de lipofuscine Légère baisse
Apparence « oeuf brouillé »
Baisse visuelle légère
Atrophie de la rétine et EPR 6/9 à 6/60
Membrane néovasculaire (20% des patients)
< 6/60
Tableau 2 : Stades de la maladie de Best
La pathologie est bien visible en autofluorescence (FAF), où la présence de lipofuscine sous-rétinienne induit une hyperfluorescence marquée, notamment dans les formes vitelliforme et pseudo-hypopion. Cette hyperfluorescence tend ensuite à s’estomper progressivement lors du stade vitelliruptif pour arriver à une hypofluorescence lors de la forme atrophique.
DellaBella, M., Schwartz, S. H., & Nehmad, L. (2018). Le PHQ-2 comme outil de dépistage de la dépression clinique dans une clinique de soins oculovisuels de première ligne. Canadian Journal of Optometry, 80(4), 17–21.
Parravano M, Petri D, Maurutto E, Lucenteforte E, Menchini F, Lanzetta P, Varano M, van Nispen RMA, Virgili G. Association Between Visual Impairment and Depression in Patients Attending Eye Clinics: A Meta-analysis. JAMA Ophthalmology. 2021 Jul 1;139(7):753-761.
Renaud J, Bédard E. Depression in the elderly with visual impairment and its association with quality of life. Clinical Intervention in Aging. 2013;8:931-43.
Taylor and Hoyt’s Pediatric Ophtalmology and Strabismus, chapitre 48 : inherited macular dystrophies, 5e édition, 2017.
Tsang, S.H., Sharma, T. (2018). Chapter 16 : Best Vitelliform Macular Dystrophy. In: Tsang, S., Sharma, T. (eds) Atlas of Inherited Retinal Diseases. Advances in Experimental Medicine and Biology, vol 1085. Springer, Cham.
https://eyewiki.org/Best_Disease_and_Bestrophinopathies consulté le 29 octobre 2025



N’oubliez pas de nous en informer.





Rendez-vous sur notre portail aoqnet.qc.ca, cliquez sur l’onglet MEMBRES en haut à droite et entrez votre nom d’utilisateur et votre mot de passe.








Cliquez ensuite sur le petit onglet bleu en haut à droite où apparaîtra votre nom.



Choisissez Mon Profil pour la mise à jour de votre compte.













Par Me Frédéric Comeau
Avocat
Avant la pandémie de coronavirus, les garanties légales étaient rarement un élément de discussion et de négociation lors de la vente d’un immeuble. Le Code civil du Québec garantit d’ailleurs qu’elles existent de plein droit, à moins de les exclure explicitement dans le contrat de vente1

Or, depuis la pandémie et la pénurie d’habitations et de logements, de plus en plus d’immeubles sont vendus sans garanties légales ou sans garanties légales et aux risques et périls de l’acheteur. Quelles sont les conséquences d’acheter sans garanties légales ou sans garanties légales et aux risques et périls de l’acheteur? Les exclusions de garanties légales possibles et leurs nuances sont exposées dans cet article pour les cas où la vente a été effectuée par un vendeur non professionnel2. Il ne concerne pas la vente par un vendeur professionnel et ses spécificités juridiques.
Le Code civil du Québec met en place deux types de garanties légales, dans le cadre de la vente d’un immeuble :
1. la garantie de propriété; 2. la garantie de qualité.
La garantie de propriété concerne les limitations de droit privé comme les servitudes, les hypothèques, les empiètements par le vendeur ou par une tierce personne à la connaissance du vendeur et les limitations de droit public comme les droits acquis ou la règlementation municipale3. La garantie de qualité concerne tout vice ou tout défaut d’un immeuble. Elle octroie un recours contre les vices cachés4. La garantie de propriété et la garantie de qualité peuvent être exclues, mais ces exclusions sont interprétées restrictivement.
II existe deux formes d’exclusion de garanties légales :
l’exclusion simple, laquelle ne prévoit pas la mention « aux risques et périls »; l’exclusion « aux risques et périls »5
L’exclusion simple est généralement libellée ainsi : « La présente vente est effectuée sans garantie légale ». Cette exclusion protège le vendeur de tout recours portant sur des éléments qui lui étaient inconnus au moment de la vente.
L’exclusion « aux risques et périls » est habituellement libellée ainsi : « La présente vente est effectuée sans garantie légale de qualité et aux risques et périls de l’acheteur. ». Cette formulation exclut tout recours, à l’exception du dol.Le dol est un recours découlant d’un vice de consentement au moment de la vente. Un acheteur doit donc démontrer que son vendeur l’a volontairement induit en erreur.
De plus, cette tromperie ne peut pas simplement résulter d’un silence. Elle doit résulter d’un acte affirmatif, comme un mensonge ou une demi-vérité6. De plus, l’utilisation de l’exclusion « aux risques et périls de l’acheteur » crée, pour l’acquéreur, la présomption qu’il a la connaissance des vices affectant l’immeuble au moment de la vente7
Ces exclusions peuvent être d’une grande pertinence lorsque le vendeur vend un immeuble qu’il ne connaît pas ou n’a jamais habité, comme un immeuble hérité par succession ou transmis à la suite d’une faillite.
Les exclusions peuvent être totales ou partielles8. Le vendeur d’un immeuble peut donc exclure une ou les deux garanties légales, totalement ou partiellement. En effet, elles pourraient entre autres convenir :
de ne pas garantir la conformité de l’immeuble à la règlementation municipale, tout en conservant la garantie de propriété pour le reste;
de ne pas garantir l’étanchéité de la toiture, mais en garantissant tout de même la qualité du reste de l’immeuble;
de limiter les garanties légales à une durée de trois ans, lesquelles s’éteignent une fois les trois années passées.
Les possibilités d’exclusions de garanties légales sont donc nombreuses et peuvent être adaptées aux particularités de chaque immeuble et de chaque transaction immobilière.
La transmission des garanties légales
Comme les garanties légales sont attachées à l’immeuble, leur effet se transmet lors de chaque vente. Cela entraîne deux conséquences principales. D’abord, le vendeur peut être responsable des problèmes qui prennent naissance pendant qu’il est propriétaire : pour ceux-ci, il donne la garantie légale aux acheteurs suivants. Ensuite, pour les problèmes existants avant qu’il devienne propriétaire, il transmet les garanties et recours qu’il avait lui-même reçus lors de l’achat de l’immeuble9
Toutefois, un acheteur subséquent ne peut pas avoir plus de droits que l’acheteur précédent. Ainsi, certaines limites, comme l’expiration des délais pour agir ou les quittances déjà accordées, demeurent opposables à tous les acheteurs suivants10
Ainsi, le vendeur peut exclure de trois façons les garanties légales11 :
1. Exclusion limitée au vendeur immédiat;
2. Exclusion limitée au vendeur immédiat et un ou plusieurs vendeurs antérieurs;
3. Exclusion au vendeur immédiat et à tous les vendeurs antérieurs.
Selon la jurisprudence actuelle, les exclusions de garanties simples et « aux risques et périls » rompent la transmission des garanties légales passées12. Toutefois, dans le cas d’une exclusion simple, il est possible d’explicitement conserver les garanties légales de vendeurs précédents en le stipulant clairement.

S’il est possible d’exclure les garanties légales, le vendeur « ne peut, en aucun cas, se dégager de ses faits personnels »13. À titre d’exemple, le vendeur qui a effectué des travaux en autoconstruction ne peut pas les exclure de la garantie des faits personnels, car ces travaux découlent de ses faits personnels14
Recommandations
Comme acheteur, il est primordial de prendre connaissance des garanties légales offertes par le vendeur pour l’immeuble. Plus les exclusions de garanties légales sont vastes, plus l’acheteur devrait être diligent et prudent dans son achat de l’immeuble. Il est donc important d’effectuer une inspection détaillée de l’immeuble avec un professionnel qualifié avant de procéder à l’achat.
À titre de vendeur, les risques des différentes garanties légales et des recours qui peuvent en découler doivent être pris en considération, notamment en ce qui concerne l’âge, l’état et la conformité de l’immeuble. Le vendeur, à tout évènement, a intérêt à déclarer toute non-conformité, toute irrégularité ou tout vice connu avant la vente au moyen de la Déclaration du vendeur. En effet, la connaissance de l’acheteur de ces problématiques protège davantage le vendeur de potentiels recours, sauf lors de manœuvres mensongères de la part du vendeur.
Si vous avez des questions au sujet des garanties légales, vous pouvez communiquer avec les avocats de votre ligne d’assistance téléphonique juridique gratuite du lundi au vendredi de 8 h à 18 h en composant le 1-877-579-7052.
1. Code civil du Québec, RLRQ c. ccq-1991, art. 1716
2. Ce texte a été inspiré par la formation délivrée par Me Isabelle Sirois, avocate et médiatrice. Cette formation intitulée « Les exclusions de garantie(s) légale(s) du vendeur en immobilier » a été livrée en septembre 2025
3. Code civil du Québec, RLRQ c. ccq-1991, art. 1723 et 1724.
4. L’Optométriste, « Transaction immobilière : quand l’acheteur découvre l’envers du décor », vol. 48, no 5, septembre et octobre 2025, p. 45-48.
5. Code civil du Québec, RLRQ c. ccq-1991, art. 1733.
6. Tremblay c. Immeubles Perron Ltée, 2024 QCCA 719, paragr. 24
7. Blais c. Laforce, 2022 QCCA 858, paragr. 6 à 9
8. Code civil du Québec, RLRQ c. ccq-1991, art. 1732.
9. Code civil du Québec, RLRQ c. ccq-1991, art. 1442.
10. Gagné c. Tcheki Mattei, 2024 QCCS 1000, paragr. 42.
11. L’Optométriste, « Bris d’équipement et retours : Que faire? », vol. 47, no 4, juillet et août 2025, p. 40-41.
12. Tremblay c. Immeubles Perron ltée, 2024 QCCA 719, par. 32; Blais c. Laforce, 2022 QCCA 858, paragr. 6 à 9.
13. Code civil du Québec, RLRQ c. ccq-1991, art. 1732.
14. Villeneuve c. L'Heureux, 1998 CanLII 11254 (C.S.)




Imagerie grand champ, sans eff ort excessif pour le patient.

Demandez votre démonstration gratuite







ZEISS CLARUS 500 La couleur réelle compte.
CLARUS fournit des images rétiniennes en couleurs vraies qui refl ètent la réalité clinique pour une prise de décision en toute confi ance.
Imagerie en couleurs
Pas de simulation logicielle. Ce que vous voyez est cliniquement réel. Plusieurs modalités d’imagerie dans un seul système FAF (vert et bleu), infrarouge, stéréo et imagerie externe.




Une confi ance diagnostique accrue : Une interprétation plus juste pour des décisions d’orientation plus pertinentes. Le champ large ne suffi t pas : la vraie couleur change tout.




Contactez votre représentant ZEISS pour plus de détails.
868-2081
Monsieur Patrick Murray, CIMMD, FCSIMD, Directeur Placements, Fonds FMOQ*
Dans un environnement économique marqué par l’incertitude, une question revient souvent chez les investisseurs : comment rendre un portefeuille plus résilient?

Au cours des dernières années, les marchés boursiers ont beaucoup progressé.
Les valorisations élevées poussent plusieurs à envisager les actifs réels. Appelés aussi « placements alternatifs », ces actifs représentent des éléments tangibles, qui évoluent différemment des marchés traditionnels et procurent des avantages distinctifs à long terme.
Que sont les actifs réels?
Les actifs réels regroupent des biens physiques, tels que des routes, des immeubles, des installations d’énergie renouvelable, des terres agricoles ou des exploitations forestières. Ils se distinguent des actions et des obligations par :
des revenus stables et prévisibles
une faible corrélation avec les marchés boursiers
des mécanismes naturels d’ajustement à l’inflation
Exemples d’actifs réels courants :
Ressources : parcs solaires, hydroélectricité
Infrastructure : routes à péage, aéroports, réseaux électriques
Immobilier : immeubles commerciaux, immeubles à vocation médicale
Forêts : bois d’œuvre, terres forestières privées
Agriculture : terres cultivées, vergers, cultures permanentes
Pourquoi intégrer des actifs réels dans un portefeuille?
1. Diversification et réduction du risque global
Un avantage important des actifs réels réside dans leur capacité à offrir des rendements intéressants, mais avec une volatilité nettement plus faible que celle des actions. Autre exemple, la volatilité de l’immobilier est inférieure à celle des obligations canadiennes, et historiquement, le rendement courant de l’immobilier dépasse de près de 4 % celui des obligations gouvernementales canadiennes à 10 ans.
2. Génération de revenus stables
Les actifs réels produisent une grande partie de leur rendement sous forme de revenus réguliers : en immobilier, environ 80 % du rendement historique provient des revenus locatifs, ce chiffre est à 65 % pour les terres agricoles.
Plusieurs structures de contrats prévoient des ajustements périodiques, ce qui contribue à maintenir le pouvoir d’achat des revenus.
3. Protection naturelle contre l’inflation
Les actifs réels disposent de mécanismes intégrés pour s’adapter à l’évolution des prix. En immobilier, les loyers sont souvent indexés; les péages routiers ou les tarifs d’utilisation d’infrastructures peuvent être ajustés; et dans le secteur énergétique, les revenus sont liés à la demande globale de l’économie.
Ces éléments permettent aux actifs réels de préserver leur valeur réelle même dans un contexte inflationniste.

Malgré ses nombreux avantages, il est important de noter que la liquidité d’un portefeuille (fonds) immobilier doit être prise en considération. Certains mécanismes existent pour aider autant le client que le gestionnaire lorsqu’un client souhaite liquider son placement. Cependant, les investisseurs pourraient subir des délais importants, pouvant aller jusqu’à deux, trois ou même quatre trimestres avant d’être remboursés.
Plusieurs catégories d’actifs réels ont démontré une appréciation constante au fil du temps :
Immobilier canadien : le rendement annuel se situe entre 8 % et 9 % à long terme1
Forêts (indice NCREIF, États-Unis1) : le rendement annuel moyen est de 10,5 % depuis 1987
Terres agricoles : grâce à une demande alimentaire durable et une offre limitée de terres cultivables, le rendement demeure stable à 9,8 % depuis 1987 (indice NCREIF, États-Unis1)
Les analyses à long terme montrent également que l’immobilier a connu très peu de trimestres négatifs sur 20 ans, et que les baisses observées étaient généralement modestes (entre 0 % et 3 %). Ces caractéristiques en font un outil efficace pour soutenir un portefeuille lorsque les marchés boursiers faiblissent.
Et l’immobilier médical?
Un actif réel à part entière
L’immobilier médical illustre bien les forces des actifs réels :
Stabilité de l’achalandage, indépendamment des cycles économiques, car les services de santé demeurent essentiels en tout temps
Taux d’occupation durablement élevés et locataires stables
Revenus prévisibles grâce à des baux à long terme
Faible sensibilité aux variations des marchés boursiers
Ces caractéristiques en font une classe d’actifs particulièrement résiliente dans un portefeuille diversifié.
Selon certaines approches, une allocation entre 10 % et 25 % en actifs réels peut être envisagée dans un portefeuille diversifié. En règle générale, l’investisseur dispose de deux possibilités :
1. Détenir directement les actifs réels
L’achat d’un immeuble ou de terres agricoles exige une expertise spécialisée, beaucoup de temps, des liquidités importantes et une gestion continue. Cette option offre un contrôle complet, mais comporte des contraintes importantes.
2. Opter pour des véhicules de placement spécialisés Il s’agit de la solution privilégiée par la majorité des investisseurs, puisqu’elle permet d’obtenir une exposition diversifiée aux actifs réels tout en évitant les exigences et la complexité de la gestion directe.
Fonds FMOQ propose des solutions permettant d’intégrer des actifs réels dans un portefeuille de façon structurée et adaptée aux besoins des professionnels de la santé du Québec. Parmi ces solutions, l’immobilier médical occupe une place particulière, en raison de sa stabilité, de sa résilience et de son absence de corrélation avec les cycles économiques. Cette catégorie d’actifs peut contribuer à renforcer un portefeuille tout en offrant une source de revenus stable et prévisible.
Les actifs réels constituent un complément efficace aux actions et aux obligations dans une stratégie de diversification. Leur capacité à générer des revenus réguliers, leur faible fréquence de rendements négatifs et leur résilience face aux cycles économiques en font des outils particulièrement utiles pour stabiliser un portefeuille.
Vous souhaitez examiner comment cette catégorie d’actifs pourrait s’intégrer à votre stratégie de placement? Communiquez avec nous pour une rencontre sans frais et sans engagement de votre part : info@fondsfmoq.com
1

1 855 587-7437
Lussier.co/AOQ

Lorsque vous souscrivez à une assurance vie ou une assurance salaire, l’assureur vous demande souvent de passer un examen médical. Si cette démarche peut sembler intimidante ou intrusive, elle est en réalité le pivot qui permet de sceller votre contrat sur des bases solides. Mais à quoi sert réellement cette évaluation et que cherchent les assureurs entre les lignes de vos résultats? Voici ce qu’il faut savoir.
Le but fondamental : évaluer le risque
L’assurance repose sur le principe de la mutualisation des risques. Pour que le système fonctionne et que les primes restent justes pour tous, l’assureur doit savoir précisément quel « risque » il accepte de couvrir.
L’examen médical sert de preuve objective. Il permet à l’assureur de :
Valider les déclarations faites dans votre questionnaire de santé.
Fixer une prime juste (le coût de votre assurance) en fonction de votre état de santé réel.
Éviter les mauvaises surprises lors d’une réclamation future (une omission involontaire pourrait invalider votre protection).
L’examen ne cherche pas à détecter chaque petit rhume, mais s’attarde sur des indicateurs de santé à long terme. Selon le montant de protection demandé, l’évaluation peut varier, mais elle permet généralement de vérifier les points suivants :
1. Les indicateurs biométriques
C’est la base de l’examen. L’infirmier ou l’infirmière mesure votre poids, votre taille et votre tension artérielle.
L’objectif : calculer votre indice de masse corporelle (IMC) et vérifier si vous souffrez d’hypertension, un facteur de risque majeur pour les maladies cardiovasculaires.
2. Le profil sanguin (lipides et glycémie)
La prise de sang est l’outil le plus révélateur pour l’assureur. Elle permet d’analyser :
Le cholestérol : pour évaluer les risques d’obstruction des artères.
Le glucose (sucre) : pour détecter un diabète de type 2 ou un état prédiabétique souvent ignoré par le client lui-même.
Les fonctions hépatiques et rénales : pour vérifier le bon fonctionnement du foie et des reins.
Bon à savoir :
3. La présence de substances (urine)
L’analyse d’urine est systématique. Elle sert principalement à détecter :
La nicotine : pour confirmer votre statut de non-fumeur ou fumeur (ce qui influence grandement la prime).
La présence de drogues : qu’elles soient récréatives ou liées à certains médicaments lourds.
Des traces de protéines ou de sang : pouvant indiquer des problèmes rénaux précoces.
4. La santé cardiaque (ECG)
Pour les montants de couverture très élevés ou pour les clients d’un certain âge, un électrocardiogramme (ECG) peut être demandé. Il permet de vérifier le rythme cardiaque et de déceler d’éventuelles anomalies du muscle cardiaque.
les résultats de votre examen sont confidentiels. Ils ne sont transmis qu’au département de tarification de l’assureur et, sur demande, à votre médecin de famille.
Pour toute question sur les critères d’admissibilité ou sur le processus d’examen médical à la souscription d’une assurance, nous vous invitons à communiquer avec l’équipe de Lussier, partenaire de l’AOQ.
1 855 587-7437
Lussier.co/AOQ

En tant qu’optométriste, votre mobilité est un atout. Que vous partagiez votre temps entre deux cliniques ou que vous transportiez des montures de démonstration et des outils de précision (comme un tonomètre portable), votre véhicule devient souvent une extension de votre bureau. Mais attention : en cas de vol ou d’accident, votre police d’assurance automobile ne couvrira probablement pas votre matériel professionnel.

1. Le choc des polices : auto, habitation ou entreprise
Il existe une confusion commune chez les professionnels au Québec. Voici la réalité technique :
L’assurance automobile : elle couvre le véhicule et ses accessoires fixes. Elle ne couvre jamais les biens meubles se trouvant à l’intérieur (votre sac, votre ordinateur ou vos outils de travail).
L’assurance habitation : elle peut couvrir vos biens personnels (vêtements, sport), mais elle limite drastiquement – souvent à 2 500 $ ou 5 000 $ – la couverture pour le matériel à usage professionnel.
L’assurance des entreprises (ou professionnelle) : c’est elle qui détient la clé. Pour que votre matériel soit couvert dans l’auto, votre police de clinique doit inclure une protection pour les « biens hors des lieux ».
2. Les pièges à éviter pour l’optométriste itinérant
Le vol dans les véhicules est un crime opportuniste fréquent dans les grands centres comme Montréal ou Québec. Posez-vous les questions suivantes :
La clause de vol par effraction : plusieurs polices exigent des traces de force visibles sur le véhicule pour payer. Si vous oubliez de verrouiller vos portières, l’assureur pourrait refuser la réclamation.
Le matériel « en transit » : votre contrat spécifie-t-il que les biens sont couverts seulement lorsqu’ils sont au cabinet, ou aussi durant le transport?
Le plafond de garantie : une mallette d’essai ou un équipement diagnostique de pointe dépasse souvent les limites standards.
3. Conseils pratiques pour protéger vos actifs
Note de l’expert : ne laissez jamais votre équipement à la vue sur le siège passager. Au Québec, le « smash and grab » prend moins de 30 secondes.
L’avenant « Biens hors des lieux » : contactez votre courtier pour confirmer que votre inventaire est couvert à 100 % de sa valeur de remplacement, même lorsqu’il est dans votre véhicule.
L’usage commercial de l’auto : si vous transportez régulièrement du matériel coûteux, assurez-vous que votre assureur auto est au courant. Cela évite bien des maux de tête lors d’un sinistre.
Documentez tout : prenez des photos de votre matériel à l’intérieur du véhicule et conservez les factures d’achat numérisées.
En résumé
Ne laissez pas une zone grise compromettre votre pratique. Une simple vérification de vos avenants peut vous éviter une perte sèche de plusieurs dizaines de milliers de dollars demain. Parlez-en à votre courtier!


Madame Corey Anne Bloom, FCPA, CPA•IFA, CFF, CFE, Membre émérite de l’ACFE Associée et leader pour la région de l’Est du Canada, Juricomptabilité, enquêtes et soutien en cas de litiges 514 228-7863 corey.bloom@mnp.ca
Monsieur Simon Gaudreau, CPA auditeur, CFE, CFF, FIS
Directeur principal, Juricomptabilité 514 906-4641 simon.gaudreau@mnp.ca
Connaissez-vous les signes de fraude et savez-vous les repérer dans votre clinique d’optométrie? Selon l’Association of Certified Fraud Examiners (ACFE), il y a dans la plupart des cas au moins un élément qui permet de déceler qu’une fraude est en train d’être commise. Savoir les détecter tôt peut atténuer les répercussions du délit. Cet article examine les signes courants de fraude et les mesures à mettre en place pour renforcer les contrôles internes. Il se penche également sur le cas d’une organisation qui a demandé à l’équipe Juricomptabilité, enquêtes et soutien en cas de litiges de MNP d’enquêter sur une fraude soupçonnée.

Pour repérer les fraudes et atténuer leurs répercussions, il faut savoir en reconnaître les signes. Dans sa publication Report to the Nations de 2024, l’ACFE affirme que les entreprises ont subi une perte médiane de 150 000 $ US aux mains de fraudeurs dont le comportement révélait au moins une anomalie préoccupante.
La situation
Un employé de longue date occupant un poste de confiance a attiré l’attention du propriétaire et dirigeant d’une organisation après la découverte de suppressions de documents électroniques et d’incohérences dans les rapports internes. Le soupçonnant de détournement d’actifs, le dirigeant questionne l’employé et se heurte à son silence et à ses réponses vagues. Celui-ci semble mal à l’aise, se montre visiblement réticent à coopérer et prend tout son temps pour produire les documents qu’on lui demande (ou ne les produit tout simplement pas). Une enquête interne sur ses activités est donc lancée.
Intervention de MNP
L’équipe Juricomptabilité, enquêtes et soutien en cas de litiges de MNP, à qui on a demandé de mener l’enquête, a commencé par examiner la trésorerie, les cartes de crédit, les prêts et les autres paiements de l’entreprise. Elle a ensuite effectué une analyse des dépenses et des mouvements dans la trésorerie, mené des entretiens et appliqué des procédures juri-informatiques qui ont notamment visé les courriels et les appareils électroniques.
L’enquête a permis de conclure que l’employé faisait depuis sept ans des virements non autorisés à des comptes personnels et une utilisation personnelle des cartes de crédit de l’organisation. Pour cacher ces détournements, il comptabilisait au nom du propriétaire des prêts fictifs aux actionnaires. L’enquête a aussi montré que la fraude s’était intensifiée dans les années suivant son divorce.
L’équipe a préparé un rapport complet qui a été déposé devant la cour et a comparu au procès à titre de témoin expert.
En étant attentif aux signes, il est possible d’enrayer rapidement une fraude avant que les pertes financières ne s’accumulent. Dans son Report to the Nations de 2024, l’ACFE souligne que 84 % des fraudeurs adoptent au moins un des comportements suivants.
Vivre au-dessus de ses moyens
Selon l’ACFE, ce comportement est celui qui dénote le plus fréquemment une fraude. Dans bon nombre de cas répertoriés, les malfaiteurs faisaient des dépenses à la fois extravagantes et incompatibles avec leur salaire ou leurs revenus connus, ce qui donnait à penser qu’ils touchaient de l’argent par d’autres moyens, par exemple des actes frauduleux.
Ces personnes sont souvent contraintes à des fraudes plus importantes et plus risquées pour maintenir un nouveau train de vie qui est difficile à camoufler et qui se révèle par conséquent comme étant l’un des indices de fraude les plus fiables.
Avoir des difficultés financières
Les difficultés financières occupent le deuxième rang des signes de fraude les plus courants. Il peut s’agir de dettes personnelles importantes, de dépenses médicales inattendues ou de frais juridiques liés à un divorce ou à une séparation. Pour recevoir une bonification de leur rémunération, certains fraudeurs peuvent trafiquer des états financiers pour donner l’impression qu’une organisation a atteint ses objectifs financiers malgré une conjoncture économique difficile. Ces situations peuvent exercer des pressions appréciables sur une personne et l’inciter à la fraude pour les résoudre. Ces pressions sont l’un des côtés du triangle de la fraude, que les circonstances favorables et les rationalisations viennent compléter. Dans une clinique d’optométrie, l’évaluation des contrôles et la mise en œuvre de mesures strictes peuvent décourager les fraudes.
Entretenir des relations étroites avec les fournisseurs et les clients
Selon l’ACFE, 20 % des personnes qui commettent une fraude entretiennent une relation étroite inhabituelle avec un fournisseur ou un client. On observe fréquemment ce type de relation dans les stratagèmes d’approvisionnement qui impliquent un coupable à l’interne ou des complices à l’interne et à l’externe qui agissent par appât du gain.
Pour atténuer ce risque de fraude financière, il faut mettre en œuvre des contrôles internes stricts, y compris la séparation des tâches pour éviter qu’une seule personne ne soit responsable de l’accueil des patients, de la sélection des fournisseurs et du traitement des paiements.
Manifester une volonté de contrôle
Selon l’ACFE, 13 % des personnes ayant commis une fraude manifestaient une volonté de contrôle ou une réticence à partager leurs responsabilités avec d’autres membres de leur organisation. Cette centralisation des pouvoirs rend la découverte des irrégularités financières plus difficile, permet aux fraudeurs de les camoufler et de continuer de commettre des méfaits.
Des mesures comme imposer la rotation des postes ou des fonctions et rendre obligatoire la prise de vacances et de congés sont certaines des stratégies simples, mais efficaces, qu’une clinique d’optométrie peut mettre en œuvre pour se protéger.
Prévenir les pertes financières et les atteintes à la réputation passe par la prise d’action immédiate, dès l’apparition des signaux d’alerte. En cas d’irrégularités, de signes inquiétants ou de soupçons d’abus, un juricomptable peut vous aider à déterminer si une fraude a été commise au sein de votre clinique d’optométrie.

V o y e z - y c l a i r a v e c n o t r e éq u i p e d é v o u é e a u x p r o f e s s i o n n e l s d e l a v u e
Nos experts peuvent vous guider dans l’identification des signes de fraude.

Corey Anne Bloom, FCPA, CPA•IFA, CFF, CFE, membre émérite de l’ACFE Associée et leader pour la région de l’Est du Canada, Juricomptabilité, enquêtes et soutien en cas de litiges | 514.228.7863 | corey.bloom@mnp.ca
Simon Gaudreau, CPA auditeur, CFE, CFF, FIS | Directeur principal, Juricomptabilité 514 906 4641 | simon gaudreau@mnp ca
Partout où mènent les affaires
MNP ca
Optométristes recherché(e)s Équipements et/ou clinique à vendre
CAP-DE-LA-MADELEINE SHERBROOKE • VICTORIAVILLE • QUÉBEC • TROIS-RIVIÈRES • RIMOUSKI • ROUYN
ST-JÉROME • JOLIETTE
BELOEIL • GRANBY • LA RÉGION DU GRAND MONTRÉAL
Temps plein / permanent / temporaire / partiel
Greiche & Scaff greiche-scaff.com
Dr André Aoun
Optométriste 514 207-9211 andre.aoun@greiche-scaff.com
Nous vous offrons des conditions exceptionnelles, une très grande flexibilité de pratique et un encadrement dynamique. Nos priorités sont vos besoins pour oeuvrer à la santé de vos patients. Parce qu’avant d’être nos clients, ils sont avant tout vos patients. Saisissez dès maintenant l’opportunité de faire partie de notre grande famille Greiche & Scaff. Notre promesse ? Votre tranquillité d’esprit. Discrétion assurée.
Temps partiel / permanent
Lunët Espace Vision lunet.ca
Dr Yannick Jarjour Optométriste 418 929-7549 yannickopto@gmail.com
Lunët Espace Vision est à la recherche d’un(e) optométriste à temps partiel pour notre succursale de Québec. Vous rejoindrez une équipe dévouée et dynamique dans un environnement vaste, épuré et avec un équipement à la fine pointe. La clientèle y est active et sympathique. Si vous êtes intéressé(e) à faire partie de notre équipe, rejoignez-nous par courriel.
Temps partiel (3 jours / semaine)
Clinique d’Optométrie
St-Gabriel
Dr Frédéric Lussier Optométriste freluss@icloud.com
Cell. 438 929-6781
Bureau : 450 835-2525
Recherche Optométriste pour St-Gabriel-de-Brandon (Lanaudière). Disponible dès maintenant. 1 à 3 journées par semaine. Pas de samedi. (4 journées par semaine serait aussi envisageable). Horaire flexible, pourrait être de jour seulement. Il y aurait possibilité d’association s’il y a un intérêt réciproque. Petite pratique de type familiale, proximité de la clientèle, liberté de pratique, environnement convivial. Une seule salle d’examen. Clinique établie depuis 25 ans, clientèle fidèle.
Temps partiel / remplacements ponctuels
Raymond et Côté, services mobiles d’optométrie www.visionrc.ca
Dr Shelton Regismarianayagam Optométriste 514 946-1010 poste #3 cv@visionrc.ca
L’équipe de Raymond et Côté est à la recherche d’optométristes désireux de varier leur pratique à travers nos cliniques visuelles mobiles au service des années. Forts de nos 31 ans d’expertise en cliniques mobiles dans la région de Montréal, nos services s’installent dans la région de Québec. Nous offrons un environnement de travail atypique et très enrichissant auprès d’une clientèle ayant de grands besoins. Que ce soit pour des besoins ponctuels ou de façon plus régulière à temps partiel, nous serons enchantés de vous accueillir dans notre belle équipe déjà composée de 6 opticiens d’ordonnances et 7 optométristes. Au plaisir de vous rencontrer!
Temps plein / partiel / permanent / temporaire
Optique Santé optiquesante.com
Dre Myriam Maltais
Optométriste
Mme Christine Michaud 418 543-2020 ou 418 590-2021 info@optiquesante.com
Chez Optique Santé, nous cherchons à offrir la flexibilité, l’humanité, l’équilibre entre la vie professionnelle, sociale et familiale, dans un environnement technologique doté d’un personnel dévoué ? Optique Santé, clinique indépendante établie depuis 35 ans au coeur de la ville de Chicoutimi, peut vous offrir cette vie équilibrée. Nous possédons 8 salles d’examen, la présence de 5 optométristes, OCT, caméras, Lipiview-Lipiflow ainsi que la technologie Neurolens. Votre vie exceptionnelle, c’est chez nous à carriereenvue.com
Temps plein / partiel / volant / permanent ou temporaire
IRIS, Le Groupe Visuel career.iris.ca/fr/optometristes
Docteure Jahel St-Jacques, optométriste 418 234-4510 jahel.st-jacques@iris.ca
La qualité des services aux patients vous tient à coeur ? Vous recherchez un environnement de pratique favorisant la collaboration interprofessionnelle, une clientèle familiale et fidèle ainsi que de l’équipement de pointe ? IRIS a des opportunités partout au Québec : Rive-Sud et RiveNord de Montréal, Laurentides, Outaouais, Lanaudière, Trois-Rivières, Sherbrooke, Québec/Lévis, Bas-St-Laurent, Charlevoix, Sept-Îles, Saguenay–Lac-St-Jean, AbitibiTémiscamingue ! Plusieurs postes d’optométristes volants et opportunités de partenariat sont disponibles ! En plus d’une remarquable qualité de pratique, plusieurs secteurs vous offriront une qualité de vie avantageuse et de nombreux attraits touristiques et activités de plein air.
Grâce à la section des petites annonces classées de la revue l’Optométriste vous faites d’une pierre deux coups : votre annonce, au coût de 25 $ par parution (taxes en sus), sera publiée dans la revue et sera distribuée aux optométristes, aux opticiens d’ordonnances, aux ophtalmologistes et aux compagnies d’optique. Elle se retrouvera également sur notre site Internet jusqu’à la parution de la prochaine revue. Vous bénéficierez donc d’une visibilité accrue.
Votre annonce doit contenir environ 50 mots et doit être au nom d’un optométriste membre de l’AOQ. Vous devez nous faire parvenir votre annonce par courriel à josee.lusignan@aoqnet.qc.ca















Temps partiel / remplacements ponctuels
Raymond et Côté, services mobiles d’optométrie visionrc.ca
Dr Shelton Regismarianayagam
Optométriste 514 946-1010 poste #3 cv@visionrc.ca
L’équipe de Raymond et Côté est à la recherche d’optométristes un jour/ semaine sur le territoire de Laval et de la Rive-Nord. Vous êtes optométriste à la recherche d’un peu d’aventure ? Nous sommes ouverts à rencontrer des professionnels de coeur qui veulent améliorer le monde. Si vous voulez explorer vos possibilités de pratique mobile en RPA et en CHSLD avec une équipe dédiée à la mission, contactez-nous pour en discuter et venir observer nos équipes sur le terrain. Nous serons enchantés de vous accueillir dans notre belle équipe déjà composée de 6 opticiens d’ordonnances et 7 optométristes. Au plaisir de vous rencontrer !
Temps partiel
MaVue Marie Trudel opticienne www.mavuemarietrudel.com
Dre Mariève Béchard
Optométriste 418 614-2810 admin@mavuemarietrudel.com












La clinique MAVUE Marie Trudel opticienne est un lieu professionnel indépendant et renommé au service d’une clientèle fidèle et familiale en croissance continuelle. Une lunetterie haut de gamme à Québec à l’approche distinctive d’une équipe d’opticiennes au cœur du quartier St-Sacrement. Un endroit relationnel positif au service d’un bien-être visuel adapté consciencieusement. Chacun de vos patients bénéficie ici de l’optimisation garantie de votre travail et prescription. Clientèle variée, en constante croissance. Possibilité d’association future. Bienvenue aux optométristes volants et aux nouveaux finissants. Stationnement inclus. Pour plus d’informations, écrire : admin@mavuemarietrudel.com










































PLATEAU-MONT-ROYAL
Temps partiel, possibilité d’association
Clinique d’optométrie
St-Joseph Opto-Réseau opto-reseau.com/fr/cliniques/ clinique-doptometriest-joseph
Dr Sylvain McMahon
Optométriste
Dre Ariane Labonté-Boyer
Optométriste
Cell. : 819 421-0550 opto.stjoseph@gmail.com
Située sur le Plateau-Mont-Royal et établie depuis 75 ans, la Clinique d’optométrie St-Joseph Opto-Réseau recherche un(e) optométriste intéressé(e) par une association au sein de notre pratique indépendante. Clinique entièrement équipée : 2 salles, OCT antérieur/postérieur, topographe, prétests faits par des assistantes, trois opticiens d’ordonnances. Clientèle fidèle et diversifiée. Ouverte 2 soirs, fermée le weekend.
Contractuel 1 semaine ou + / année
Optique Donnelly optiquedonnelly.com
Dre Annie Dionne
Optométriste 514 694-0836
Demandez Steffan steffandonnelly_ood@hotmail.com
Optique Donnelly est à la recherche d’optométristes pour accompagner ses équipes d’opticiens d’ordonnances à travers le Nunavik. Saisissez l’opportunité de découvrir les communautés du Grand Nord québécois. 14 villages de la Baie d’Hudson et d’Ungava vous attendent. Les voyages sont de 6 jours. Déplacements et hébergements pris en charge. Rémunération jusqu’à 2 000 $ / jour de travail + perdiem. Expérience extraordinaire et dépaysement garanti.
Temps plein / partiel / permanent
Clinique Visuelle Beauport OptoPlus optoplus.com
Dre Valérie Vigneault Optométriste 418 667-5778 cliniquebeauport@videotron.ca
OptoPlus Beauport recherche optométriste selon le nombre de jours ou d’heures désirés. Entièrement rénovée, la clinique possède : OCT, topographe, laboratoire, vaste choix de montures de marque. Horaire selon vos préférences. Personnel impliqué et attentionné. Partenariat possible.
Temps partiel
Optik Avenue Optométristes optikavenue.com
Dr Michael Toulch
Optométriste
Madame Audrey Brennan 514 937-0446 info@optikavenue.com
Nous recherchons un(e) optométriste avec disponibilités les mercredis ainsi que deux samedis par mois, pour se joindre à notre équipe. Optométriste et opticien(ne) d'ordonnances.
Temps partiel (2 jours / semaine) / permanent
Centre d’optique
Martine Monette www.centreoptiquemonette.com
Dr Pierre Bannon
Optométriste
Mme Martine Monette 514 776-7802
martine.monette@yahoo.ca
Recherche un(e) optométriste 2 jrs / semaine. Clinique établie depuis 70 ans, axée sur le service à la clientèle, ouverte 6 jours ∕ semaine, n’est pas dans le réseau. Clientèle variée (enfants, adultes, aînés). Clinique située aux Halles de Saint-Jean-sur-Richelieu.
Temps plein / partiel
Opto-Réseau L’Optométriste opto-reseau.com/fr/cliniques/ loptometriste-gatineau
Dr Serge Drouin
Optométriste
Marie-Josée ou Debbie 819 669-2019
loptométriste@loptométriste.com
NOUS RECRUTONS - OPTOMÉTRISTE et OPTICIEN(NE) D’ORDONNANCES. Nous recherchons un(e) optométriste et un(e) opticien(ne) d’ordonnances pour se joindre à notre équipe dynamique et bienveillante! Que vous soyez expérimenté(e) ou en début de carrière, nous serions ravis de vous rencontrer.
Ce que nous offrons :
- Horaire 100% flexible, temps plein ou temps partiel selon vos besoins;
- Équipement de pointe (OCT, Octopus, champ visuel avec casque VR, Handyref...);
- Salle autonome avec biomicroscope et réfractomètre pour les opticien(ne)s d’ordonnances;
- Possibilité de développer vos intérêts cliniques (pédiatrie, sécheresse, lentilles spécialisées...);
- Deux milieux de pratique : urbain (Gatineau) et régional (St-André-Avellin);
- Environnement professionnel, respectueux et organisé avec une équipe bien formée.
Intéressé(e) ou curieux(se)? N’hésitez pas à nous contacter au 819 669-2019 (demandez pour Serge, Marie-Josée ou Debbie) ou par courriel : loptometriste@loptometriste.com Nous avons hâte de vous rencontrer!
dans des lentilles mensuelles ou à usage unique.

Les adultes passent en moyenne 11 heures par jour sur des appareils numériques1.
MyDay Energys MD et Biofinity Energys MD
sont les seules lentilles cornéennes à offrir la combinaison unique des technologies DigitalBoost MC et Aquaform MD conçues pour aider à réduire la fatigue et la sécheresse oculaires associées à l’utilisation d’appareils numériques.
Un confort incroyable conçu pour le monde d’aujourd’hui.*





Par la docteure Emanuelle Bédard
Optométriste, M.Sc

Une femme de 19 ans rapporte un seul point noir dans sa vision centrale OS depuis plusieurs mois. Elle n’a aucun flash lumineux ni flottants. AV 6/4,5 OD et OS. La rétine est saine avec dilatation et il n’y a pas de PVD.
La photo et le scan OCT dépistage (Raster) est sans particularité (Figure 1). On peut cependant deviner un « reverse shadow » dans les couches de la choroide à la fovéa.
Le scan radial permet des images de meilleure qualité que la Raster dépistage (Figure 2). On y voit clairement une atteinte dans les couches profondes de la rétine, soit à l’EPR.
La rétinopathie solaire est parfois observée de manière binoculaire chez les adeptes de la méthodes de Bates, soit une technique élaborée par un ophtalmologiste dans le début des années 1900 pour « guérir » la myopie en regardant le soleil. Bien que prouvée inefficace et même dangereuse, on retrouve encore aujourd’hui des gens qui pratiquent cette méthode.
La rétinopathie solaire monoculaire suggère plutôt l’action d’un laser. Dans le présent cas, la patiente avait acheté un pointeur laser puissant sur le web et a pointé le laser dans son oeil par curiosité. Les classes de laser 3b et plus (>5mW) peuvent causer des dommages rétiniens après 1/100sec d’exposition directe à la rétine. Ici, le dommage est permanent puisque les photorécepteurs sont morts.
Perle clinique
Même si l’OCT dépistage de type Raster est très rapide et offre des images correctes, en présence de symptômes il est préférable d’ajouter une autre stratégie comme le scan radial, line ou 3D macula (ultra-fine) pour avoir des images de meilleure qualité.
https://www.canada.ca/fr/sante-canada/services/securite-et-risque-poursante/radiation/sources-rayonnements-quotidien/appareils-laser.html
Bhende M, Shetty S, Parthasarathy MK, Ramya S. Optical coherence tomography: A guide to interpretation of common macular diseases. Indian J Ophthalmol. 2018 Jan;66(1):20-35.
Exposing the Secrets of Fringe Eye Care, https://www.reviewofoptometry. com/article/exposing-the-secrets-of-fringe-eye-care Bates method, https://en.wikipedia.org/wiki/Bates_method#cite_notepollack-2

Essayez notre tarificateur en ligne, un outil intuitif et rapide, parfait pour les professionnels occupés comme vous :
Visitez notre page web en scannant le code QR ci-dessous
Sélectionnez l’onglet Assurance automobile-habitation
Choisissez l’option Soumission automobile en ligne
Obtenez votre soumission en quelques minutes, sans engagement.

